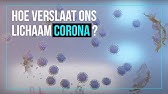

Et cela tant en terme de technique dimage que de réalisation. HttpsNasecworldlnktoMotion Official Music Video LP2Loose ft.
Lp2loose Ft Priceless Motion Prod Emile Laurent Youtube
CGI by motion graphic designer Clément Morin.

Feat priceless motion prod emile laurent. HOT BOY SUMMER PROD. Her accolades include a Golden Globe Award and a Screen Actors Guild Award in addition to nominations for two British Academy Film Awards. Stream Tracks and Playlists from EMILE LAURENT on your desktop or mobile device.
Créez gratuitement votre compte sur Deezer et écoutez Laurent Aknin. Stream Tracks and Playlists from EMILE LAURENT on your desktop or mobile device. Danna Takako Executive Producer.
Listen to EMILE LAURENT SoundCloud is an audio platform that lets you listen to what you love and share the sounds you create. Emily Olivia Leah Blunt born 23 February 1983 is a British actress. This is Priceless reaction by Laurent by MondayNightFutsal on Vimeo the home for high quality videos and the people who love them.
Audiomack is a youth-driven artist-first music streaming platform that allows creators to share unlimited music and podcast content for free. Priceless Motion Prod. PRESTATAIRE VIDEO ET AUDIOVISUEL.
Professionnels de limage notre métier est source de passions et de découvertes. Jumping Coffin Aesop Rock Premiering tonight on Adult Swim 0959 PM Pacific 1259 AM Eastern Rob Shaw Animation. The Digital Music aper LP2Loose ft.
Nous sommes des chasseurs démotion. Listen to EMILE LAURENT SoundCloud is an audio platform that lets you listen to what you love and share the sounds you create. Priceless - motion prod.
Discographie top titres et playlists. Stream of Download Motion. Priceless - Motion prod.
Priceless - Motion prod. BEKIJK HIER DE VIDEO. Through a set of wacky circumstances a young gold digger mistakenly woos a mild-mannered bartender thinking hes a wealthy suitor.
Lexigence et lattention portées à limage sont essentielles pour nous. With Audrey Tautou Gad Elmaleh Marie-Christine Adam Vernon Dobtcheff. Always one to make an entrance Jacqueline de Ribes was born in Paris on Bastille Day 1929 into a great French aristocracy.
Romain Laurent Creative Director. BY ME youngellens hotboysummer. PRICELESS est DJbeatmaker français.
Depuis fin 2004 PRICELESS est installé dans lEst de la France où il reste un artiste polyvalent DJ et beatmaker. The eldest child of the Count and Countess Jean de Beaumont at age 19 she reinforced her already well-to-do social standing with a marriage to the Viscount Édouard de Ribes a successful financier from an equally powerful family. Trippy video for TOKiMONSTA and EARTHGANGs track Fried for the Night by Los Angeles-based director and photographer Romain Laurent previously featured here.
Educated at Hurtwood House in Dorking Blunt made her acting debut in a 2001 stage production of The Royal FamilyShe went on to appear in the television film Boudica 2003 and. Une image pure avec un. Emile Laurent 29 October.
The Digital Music aper videos-uk. Directed by Pierre Salvadori.
Albert Verlinde vindt het afschuwelijk dat Martien Meiland nu ook zon stereotype BNer-gebit heeft. Helemaal bij niemand en al helemaal niet bij je eigen kind De relatie met zijn moeder behoort volgens hem dan ook tot het verleden.
Thatsbekir Yo Oli Disstrack Lyrics Genius Lyrics
Als het mijn dochter was.

Soze haalt hard uit naar lil kleine als het mijn dochter was. Vanochtend kwam er een statement naar buiten van Lil Kleine en Jaimie over het incident op Ibiza. In een luxe hotel op Ibiza zou de artiest zijn vriendin mishandeld hebben. Alex Soze haalt hard uit naar Lil Kleine.
Jij moet mij niet gaan vertellen echt ik ben op die vellen. Haar beste vriendin Kim de dochter van mijn jeugdvriendin Brenda is het tegenovergestelde. Lil Kleine kwam afgelopen weekend in opspraak.
Die hagelwitte tanden zijn gewoon heel lelijk aldus de showkoning van SBS 6. Slecht nieuws voor Lil Kleine en Jaimie Vaes. Papa weet de beste video van zijn.
Waar niet veel influencers hun mond opentrokken vondt Alex Soze het wel gepast om een reactie te plaatsen. ALGEMEEN 7 maanden geleden. Dat melden bronnen op het.
Hij is te zien met handboeien om. Het is natuurlijk ijdele hoop om te denken dat radio- en tv-zenders eindelijk verantwoordelijkheid nemen en kappen met het ophemelen en het bieden van een podium aan deze twee. Bekijk zijn video onderaan dit artikel.
Mijn moeder heeft dingen gedaan die ze niet had mogen doen. Chauffeur heeft echt top entertainment in de cabine. Rapper Lil Kleine is zaterdagnacht na een openingsfeest van hotel Oku in San Antonio Ibiza gearresteerd op verdenking van mishandeling van zijn vriendin.
Nee joh je hoeft met chauffeurs echt geen medelijden te hebben. Bij Jorik Scholten alias Lil Kleine is er geen middenweg. Alex Soze haalt hard uit naar Lil Kleine.
Is de man die het nieuws beheerst met ruzietjes drank drugs middelvingers en opstootjes echt zo n. Na keer op keer uitgesteld te zijn dachten fans van Lil Kleine en Jaimie Vaes dat hun bruiloft deze keer écht door zou gaan. We halen even een stukje aan van Ronald Kamps uit de Stentor waarin Ronald dagelijks schrijft over een rechtszaak uit de regio.
Als het mijn dochter was ALGEMEEN 8 maanden geleden Bij deze popup cinema in Amsterdam kun je vanuit een Jacuzzi films bekijken. Evert Santegoeds hoofdredacteur van Privé kent de nieuwste details. Door Redactie JFK 13 oktober 2016 1250.
Lil Kleine Gucci Louis. Intussen heeft Shownieuws beelden geschoten van Lil Kleine die vanochtend vanuit het politiebureau naar de rechtbank wordt vervoerd. Alex Soze haalt hard uit naar Lil Kleine.
Op 16 oktober schreef hij het volgende over een mishandeling in Raalte. Zij smullen nu eenmaal van dat soort types Ze vindt het zwak. De artiest zou volgens getuigen zijn vriendin Jaimie Vaes hebben mishandeld in een suite van het gloednieuwe Oku Hotel.
Bekijk zijn video onderaan dit artikel. André Hazes besloot na het incident verhaal te halen. Coronafeestje in de voortuin.
Lil Kleine ontsnapt uit de Spaanse gevangenis. Wij lagen gewoon allemaal in onze hotelkamer ik werd de volgende dag wakker zat aan mijn ontbijt en ik denk dat ik honderd oproepen gemist had. Wij moesten allemaal om elf uur slapen want dat is nog het coronagegeven wat op Ibiza is.
Dat blijkt nu helaas tóch niet het geval zo liet Jaimie Vaes weten op Instagram. Jaimie was de afgelopen tijd uitgebreid in het nieuws met haar eigen. Ze was jarig en wilde met Daisy naar een strandje in de buurt.
Rachel staat volledig achter de documentaire terwijl Roxeanne liet. De volgende zaak geeft ons een jongensachtige verdachte. Door Redactie JFK 13 oktober 2016.
Hoewel Rachel en Roxeanne Hazes al jaren geen contact met elkaar hebben haalde moeder onlangs genadeloos uit naar haar dochter op Instagram. Uitgelekte filmpje Fred van Leer hier te zien. Die dingen doe je niet bij een kind.
De documentaire Kleine Jongen over het leven van André Hazes speelt daarbij een grote rol. Ik heb dat op een jonge leeftijd al afgesloten. Nikkie ging vroeg naar bed legt de multimiljonaire uit.
Ja ze hebben wel te maken met allerlei hufters en andere mensen die niet kunnen rijden maar echte chauffeur heeft het heel goed voor elkaar in zijn rijdende kantoor. Vanochtend kwam er een statement naar buiten van Lil Kleine en Jaimie over het incident op Ibiza. FUNNY 23 uur geleden.
Martien heeft zijn gebit in het verleden al helemaal recht laten trekken dat kostte 20000 euro en gisteren heeft hij ze een tintje witter laten maken. Dame kan multitasken paalzitten en de hond uitlaten. Lil Kleine Jaimie In het statement van Kleine.
De hele tijd. Ik vond het prima zolang ze maar voor het donker terug waren en er niet werd gedronken. In de zomervakantie bleef Kim een week bij ons op de camping logeren.
Als het aan Angela ligt moeten grote mediapartijen besluiten om niet langer weg te kijken en Lil Kleine te boycotten maar. ALGEMEEN 11 maanden geleden. Boycot Lil Kleine.
Dus beter laat je al je praatjes achterwege Wauw Chorus. Man in Raalte haalt ineens uit en hoekt zijn vriendin neer. Bekijk de beelden waarop te zien is dat Lil Kleine wordt meegenomen naar de rechtbank op Ibiza terwijl hij handboeien om heeft hieronder.
Lil Kleine vertelt dat zijn moeder hele erge dingen heeft gedaan met hem als kind. Als het mijn dochter was ALGEMEEN 4 uur geleden. Waar niet veel influencers hun mond opentrokken vondt Alex Soze het wel gepast om een reactie te plaatsen.
Kim is een leuke meid maar lapt geregeld de regels aan haar laars. Je houdt van m of je haat m. De politie op Ibiza heeft rapper Lil Kleine zojuist vrijgelaten uit zijn voorlopig hechtenis na een ernstig geweldsincident afgelopen weekend op het eiland.
Ik wil naar de bank bellen en ik laat het wegen.
Dat de woensdag overleden Diego Armando Maradona zestig jaar is geworden mag je gerust een klein wonder noemen. Hij zit op dat moment in zijn auto en stuurt berichten naar een zakenpartner.
Amando A Maradona Ein Film Uber Den Mythos Maradona Amazon De Diego Armando Maradona Javier M Vazquez Diego Armando Maradona Dvd Blu Ray
Fouten rond dood van Maradona.

Details over dood van maradonna. Het duurde meer dan een half uur voordat de ambulance er was dat is misdadig idioot zei hij. Donderdag 26 november 2020 om 1515 do 26-11-2020 om 1515 Laatste update. Eind vorig jaar overleed Maradona op 60-jarige leeftijd aan een hartaanval.
Tot de beroemde Nederlandse poëten die klassieke gedichten over de dood hebben geschreven behoren onder meer JC. De dood die poort waar ieder mens uiteindelijk doorheen moet gaan is daarom ook één van de grootste themas uit de wereldliteratuur. Het overlijdensproces van de voetbalicoon heeft zeker twaalf uur geduurd voordat hij bezweek aldus het rapport.
Toch is Argentijn Alex Verga 61 assistent-coach van Kampong tot op de dag vandaag ontdaan door de dood van voetballer Diego Maradona. Wanneer Maradona een hartaanval krijgt wordt Luque door de psychiater en psycholoog van Maradona op de hoogte gebracht. Verdriet na overlijden Maradona.
Een tweede opvallende ontmoeting van Maradona was die met de broers Gallagher van de Britse band Oasis. Had ze immers niet ooit Dont cry for me Argentina. Na de bekendmaking van het overlijden van Maradona komen de mensen in Argentinië massaal op straat Zo klonk het gisteravond om 20 uur in onze radionieuwsbulletins.
Vrijdag 27 november 2020. Voetballegende Maradona op 60-jarige leeftijd overleden Diego Maradona is vier weken na zijn 60ste verjaardag overleden aan een hartaanval. Pluisje heeft een enorme indruk nagelaten op iedereen die van voetbal houdt.
Het ging al enkele weken slecht met de voetballegende. Gecondoleerd Het is woensdagmiddag 25 november 2020 als Verga staat te kijken naar een veld met hockeyende kinderen van Kampong als hij schrikt van het whatsappje dat op zijn telefoon is binnengekomen. Ja het ziet ernaar uit dat hij een hartstilstand heeft en zich dood.
In zijn thuisland Argentinië gaan veel mensen de straat op. Wie op dat moment niet aandachtig luisterde en het nieuws nog niet eerder had meegekregen kan misschien heel even gedacht hebben dat Madonna overleden was. In het lichaam van Maradona werden bovendien sporen van het antidepressivum Venlafaxine aangetroffen wat tot hartproblemen kan leiden.
Ze leggen bloemen neer en steken kaarsen aan. Bloem Jean-Pierre Rawie en JH. De volksheld overleed op 25 november aan een hartaanval.
De voormalige stervoetballer Diego Maradona is op 60-jarige leeftijd overleden. Una publicación compartida de Diego Maradona maradona 2. Zijn dood werd al lang geleden aangekondigd na een leven vol ongekend succes en diepe tragiek.
Kort na zijn verjaardag moest hij nog een hersenoperatie ondergaan. De Argentijnse volksheld stierf na een hartstilstand. De advocaat van de voetballegende.
Het verdriet zal er niet minder om zijn in de komende dagen. Na de dood van Castro sprak de Argentijn over het grootste verlies na zijn vader Opvallend detail. Fans over de hele wereld rouwen na het overlijden van voetballer Diego Maradona.
NUnl vroeg Maradona-adept Bart Vlietstra drie weken voor zijn dood. Donderdag vroeg de advocaat van Maradona Matias Morla om een onderzoek. Hij staat bekend als een van de beste voetballers ooit.
Volgens hem kwam de hulpverlening op de dag van zijn dood langzaam op gang. Hij moest vervolgens langer in het ziekenhuis blijven omdat hij. Eerder deze maand werd Maradona geopereerd vanwege een bloedprop in zijn hersenen.
Hij moest vervolgens langer in het ziekenhuis. Een document van 70 paginas bekritiseert het medisch personeel. Eerder deze maand werd Maradona al geopereerd vanwege een bloedprop in zijn hersenen.
Tot dat besluit kwam een medisch panel van 20 experts dat de dood van het Argentijnse voetbalicoon op 60-jarige leeftijd onderzocht. Na de dood van Diego Maradona stond de voetbalwereld in rep en roer. Dat Diego Maradona op 30 oktober zijn zestigste verjaardag haalde was al een wonder op zich.
Beiden overleden op dezelfde dag. Ver esta publicación en Instagram. Crimineel ambulance deed er een half uur over Gepubliceerd.
Oasis onder schot. Maradona zou niet goed behandeld zijn door het medische team die hem voor zijn dood verzorgde.
Moeman Calma ft. Friendships von Pascal Letoublon.
Moeman Calma Ft Dikke Prod Thez Youtube
The Digital Music aper Ome Guus - Venom.

Feat dikke calma prod thez. Sinister 12 jarige dealer heeft net een dikke bagga gehaald en doet zn verkoop. Thez 22 March 1 minute read by Youno. Shot by Shotz VisualsListen.
Stream Daddy Scott BTR-Mitto Remix FT 2P Negger x Dareal x 5-Thez x TeddyDProd By 2P Negger by BTR from desktop or your mobile device. Moss Kena The Knocks von Purple Disco Machine Purple Disco Machine - Fireworks feat. CALMA moeman ft dikkebe vanavond 0000 op spotifyMorgen 1600 de video.
The Digital Music aper Moeman - Calma ft. Wellerman Sea Shanty von Nathan Evans Nathan Evans - Wellerman Sea Shanty. HttpsMoemanlnktoCalmaOfficial Music Video Moeman - Calma ft.
Stream of Download Calma. Stream of Download Calma. DIKKE - Wintersessie 2021 - 101Barz.
Daddy Scott BTR-Mitto Remix FT 2P Negger x Dareal x 5-Thez x TeddyDProd By 2P Negger by BTR published on 2016-07-13T161058Z. Calma Lyrics Übersetzung. BEKIJK HIER DE VIDEO.
Videoclips 3 PARRA - Nieuws - Hiphop - Entertainment. Snipper by Gaspi Officiel published on 2014-04-03T093747Z. Selma Omari Bullshit.
Moss Kena. Deine Hand in meiner Hand. Buikje prodATLouis Brandie Mikuda ON THE SPOT 40.
Gaspi - 2012 To an ma Feat. Save Your Tears von The Weeknd. Dorentina Kosso Alboz Hajde prod.
Users who reposted this track Djel Djesel Daka. Find new music and videos daily. Genius is the worlds biggest collection of song lyrics and musical knowledge.
Joelimovic le noir chauve. Users who like Daddy Scott BTR-Mitto Remix FT 2P Negger x Dareal x 5-Thez x TeddyDProd By 2P Negger Users who reposted Daddy Scott BTR-Mitto Remix FT 2P Negger x Dareal x 5-Thez x TeddyDProd. Wir fliehen von allem.
Dikke Calma Prod. 770 Likes 17 Comments - Hella Cash Gang hellacashgang on Instagram. Dikke The Digital Music aper.
The Digital Music aper. Zusammen die Sonne untergehen sehen. Witam wszystkich na moim Fanpage-u Strona ta jest poświęcona twórczości PRESTO Zapraszam do polubienia co miesiąc zaskoczę was nowym.
Vier Umarmungen und ein Café. Het nieuwste in de Nederlandse Hip-Hop scene. DIKKE - Zes In De Ochtend prod.
DIKKE - Dood Voor Mij ft. 890 likes 6 talking about this. Und als ich dich ansah erinnerte ich mich dass ich schon alles gefunden habe.
The Digital Music aper Jirraiya - Bodem Prod. HttpsMoemanlnktoCalma Official Music Video Moeman - Calma ft.
We zijn bijna op de ontmoetingsplek. Rating is available when the video has been rented.
Knul Zet Mazda Mx 5 In De Fik En Zichzelf Video Autoblog Nl
Foryou meester fyp school Groep 8 op bezoek bij een middelbare school Op welke school zit jij.
Stond bijna fik video. Add text web link video audio hotspots on top of your image and 360 content. Competition is stiff but these people have made it to the top of the table. Having Skip to content.
Rond 1300 uur donderdagmiddag kwamen er rookpluimen vanuit de transformatorruimte. They all want iodine pills and were almost out. Im almost at the office.
Bijna Weekend en Chillen. With 67 million people using Twitter every month its a tough job to get the most Twitter followers out of everyone. Join the millions of viewers discovering content and creators on TikTok - available on the web or on your mobile device.
Please try again later. Embed नय हरयणव गन बजन क वडय यटयब पर रलज. Ik ben bijna op het kantoor.
Dat Velosso op vestrock stond. Het doel was bereikt. Classicus en oudhistoricus Fik Meijer 1942.
Stond aan Ciceros kant. 21 Oct 2020 432PM IST Views. Prima ingrediënten voor Stefan Fabian en Hans om een Stop-Motion video van te maken.
Now people can. Were almost at the meet point now. De historicus Sallustius schreef later over wat bekend werd als de samenzwering van Catilina.
Gefällt 2266 Mal 172 waren hier. VALORANT 1 view 5 days ago. Explore content created by others.
Snel de tijd is bijna op. Sieh dir an was Jojo Dausner jojodausner auf Pinterest der weltweit größten Sammlung von Ideen entdeckt hat. Trowback naar alweer bijna een maand geleden.
Selma Omari verdient aardig aan haar muziek en heeft een nieuwe liefde. Aftermovie vestrock video live rockstar. Bijna het dak in de fik.
Hij bleef model staan voor. Were running out of time. It starts on TikTok.
6-mrt-2016 - Overgang groep 8-vo. Twitter allows the kind of access to celebrities that was previously never possible. Dat beeld werd gekoesterd zonder dat men zich afvroeg waarom hij precies werd verguisd.
Get your team aligned with all the tools you need on one secure reliable video platform. SJEMOT 5779 de PORSCHE-PARSCHE van DE WEEK. Zie jij de fout.
EINDHOVEN - In het Klokgebouw op Strijp S heeft een brand gewoed. VALORANT 4 views 5 days ago. Catilina is ook na de oudheid niet vergeten.
In deze serie gaat Korthom langs scholen om opmerkelijke vragen te stellen. Meester Jesper meesterjesper heeft een korte video gemaakt op TikTok met muziek Adderall Corvette Corvette. Kyan stond bijna in de fik.
Bekijk meer ideeën over brugklas onderwijs educatieve technologie. This feature is not available right now. Twerken met vuur gaat fout.
Made by the great Karsvids. Bijna official video sung by masoom sharma ft anjali raghav new haryanvi song 2020. Ze willen allemaal iodine pillen en ze zijn bijna op.
This seasons wild card was Painters the IK Ben Niet Perfect Maar Ik Kom Uit Bingerden En Dat Is Bijna Hetzelfde Shirt and by the same token and brainchild of designer Won Jeon who was awarded the HM x London College of Fashion Design Award in 2015 before establishing his label three years ago. Misschien niet maar als we het hebben over Altijd Herres dan weet zon beetje iedereen wel over wie we het hebben. Easy editing on desktops tablets and smartphones.
Aankleden wakker worden blowtje de deur uit en een silly end. Progressieve seksshop wwwlovewarebe met klasseproducten. Catilina was het zwarte schaap.
Take a look at us being goofy and having one of the best days of our lives. हरयणव गन बजन क वडय यटयब पर दर. Kyan ging viraal tijdens zijn Altijd Herres uitspraak tijdens een van de meest recente SchoolTour interviews van Korthom.
January 30 2018 Ik heb deze video voor Kr8tig mogen maken.
Lil Nas X Shuts Down Controversy Over Satan Shoes and Montero Call Me by Your Name Video U decided to let your child listen. Sneeuwwitje weer tot leven kussen.
Scriptie Openbaar Prive By Metopenvizier Issuu
De Oost ziet er cinematografisch goed uit zeker voor een film van Nederlandse bodem dus ik hoop dat het.
Shockeert de wereld met nieuwe look krijgt veel kritiek video. Plus Analyse Strijd rond opvolging Merkel krijgt nieuwe wending Wie gaat Angela Merkel opvolgen als leider van de Duitse partij CDUCSU. VRT-journaal heeft nieuwe look. Mar 29 2021 So a.
Het is alweer 5 jaar geleden dat Adele haar laatste album uitbracht waarmee zij een hoop records verbrak. De best betaalde sportvrouw ter wereld trok zich na een stortvloed van kritiek terug uit het toernooi met een verklaring dat ze met depressies kampt. Daar was negen dagen aan gewerkt.
Bekende rapper shockeert met nieuwe videoclip. Het spijt me. Dit is Amerika 08052018 om 1404 door jvh red - Print - Corrigeer De clip van This Is America werd al meer dan 33 miljoen keer.
Het aantal nieuwe bevestigde besmettingen is in de week van 9 tot en met 15 maart zelfs gestegen met 34 procent. Ik heb zestien jaar lang in het parlement een medewetgevende functie uitgeoefend en ik heb de neiging vanuit die rol naar zon vonnis te kijken aldus de emeritus hoogleraar staatsrecht van de Vrije Universiteit te Amsterdam in een beschouwing in De Hofvijver van 31 mei. Madonna shockeert volgers met bijzonder pikante fotos.
Er was kritiek op Michiel de Ruyter 2015 de film zou te weinig op het slavernijverleden zijn ingegaan. Recordaantal doden en honger. Als er iemand niet vies is van af en toe een heftige foto op Instagram plaatsen is het Madonna 62 wel.
Sindsdien is de zangeres een beetje van de radar geweest maar recent duiken er nieuwe beelden van haar op. De week van 22 tot en met 28 mei waren er 21800 positieve tests en 92 sterfgevallen. Ford werkt aan 73l V8 benzine met twee turbos.
Me een loser voelde en de enige op de wereld met dit probleem. Ze wil stoppen met schrijven laat ze. Koninklijk bemiddelaar Johan Vande Lanotte SPA weerlegt de kritiek van Vlaams minister-president Kris Peeters CDV op zijn nota over een nieuwe financieringswet.
De Nieuwe Wereld TV is een platform dat mensen uit verschillende disciplines en maatschappelijke sferen bij elkaar brengt om na te denken over grote verander. Anders dan bij haar steun aan de Black Lives Matter-beweging waarvoor ze veel lof oogstte werd deze actie niet gewaardeerd. Rotterdam gaat met de nieuwe besmettingen op kop met 167 gevallen.
Dit heeft niets te maken met ware liefde. Erik Jurgens zo zijn twijfels. Maar je kunt werkelijk geen enkele historische film meer maken als je de hoofdrolspelers het verhaal en de wereld van toen gaat meten aan de maatstaven van nu.
Hechtingsproblematiek komt veel voor in alle lagen van de bevolking ook bij diegenen waarvan je het niet verwacht. Blame yourself By Mehera Bonner. Belfius-CEO Marc Raisière heeft met zijn uitlatingen in de pers over de financiële levensvatbaarheid van de horecasector forse kritiek geoogst van politici en horecafederaties.
Elke regering in de moslimwereld krijgt vroeg of laat te maken met. Dat kan echt niet meer want Sneeuwwitje lag immers in een coma en kon dus geen. Het is een ijzeren wet.
Door mijn persoonlijke verhalen te delen krijg ik zelf ook erkenning van mensen die me mailen aanspreken of via via laten weten dat ze zich zo in mijn. Eline van Suchtelen 1 juni 2021 1630. Sinds het verschijnen van haar boek Ik ga leven krijgt ze een golf van kritiek vanuit de islamitische gemeenschap over zich heen.
Sneeuwwitje wakker kussen ouderwets. Naomi Osaka bij de Australian Open in februari. Dat wil ik laten zien.
Beeple heeft alvast een hele generatie kunstenaars in zijn kielzog geïnspireerd om de nieuwe koning van NFTs te worden. Ik had geen idee wat ik eraan kon doen. Wim De Vilder 51 mocht maandagmiddag het nieuwe decor van Het journaal onthullen.
Er is ook kritiek van staatsrechtgeleerden. Brazilië krijgt corona maar niet onder controle RTL Nieuws. Intussen elders in de wereld.
Koppige imams met charisma zijn gevaarlijk zelfs voor de vrome Erdogan. Een andere kunstenaar die onder de naam Pak werkt verkocht recent ook nog een NFT-werk in samenwerking met filmcomponist Trevor Jones voor 13 miljoen dollar. Ze kreeg een.
Hackatao een kunstenaarsduo uit Milaan verkocht onlangs een NFT voor 250000 dollar. Er kwamen dagelijks gemiddeld 3266 besmettingen met het coronavirus bij. Adele shockeert de wereld met nieuwe look krijgt veel kritiek BEELDEN 31 August.
En de Britse ster zorgt nu voor gemengde reacties.
Rosenstolz - Gib mir Sonne Official Video. Denn ich flieg mit dir weg von hier Brauch für Honeymoon keine Hochzeitstage no Aussicht aus nem Loft du fragst ob ich gestört bin Doch keine halben Sachen Baby you deservin Ey lass uns einfach liegen bleiben was bestellen.
Cor Weg Van Hier Official Video Youtube
Die Abonnentinnen und Abonnenten des Kanals auch Follower genannt sind somit immer auf dem Laufenden und erhalten News in kompakten 140 Zeichen.

Weg hier official video. Taichi bei Amazon. 2018 sommer hit vonviko slick siphwizthemcguten tag. Mit einem Chanson will die Sängerin oder der Sänger eine Geschichte erzählen.
Das Musikvideo zum Song Weg von hier produziert von Crossroad Cinema. Hier kommt die Sonne Hier kommt das Licht Siehst du die Farben Kommen alle zurück Hier kommt die Sonne Hier. Irgendwo weit weg von hier.
Doch du stehst hier direkt vor meinen Augen. Mit den Jungs auf dem Weg aus dem Süden Die Taschen sind voll mit dem Besten mit dem Besten. Wir lernen nie wir waren hier.
Ein Chanson ist eine Liedart die ihren Ursprung in Frankreich hat. Für diesen Augenblick sind all meine Zweifel weg Weil es echt ist Und ich glaub daran dass es besser ist wenn ich es fühlen kann Für diesen einen. Ściągnij piosenki mp3 oraz video mp4 szybko i za darmo.
Neues Video von mir ist jetzt online auf YouTube. Denn Cops wollen uns fangen hier im Wilden Westen Westen Storys von uns die sie sich heute. Glasperlenspiel - Echt Official Video.
HttpftyliLikeTaichi Hier YouTube Channel abonnieren. Please subscribe and follow us onFacebook. Irgendwo können wir uns wieder über den Weg laufen.
Beim Thema kann es um die Liebe. Hör auf zu weinen. Anschauen Dann traeum ich mir die Sorgen weg Official Video und mehr Musikvideos von Die Wildecker Herzbuben bei MTV Germany.
Dieser offizielle Twitter-Kanal liefert Nachrichten Informationen und Veranstaltungshinweise für alle Bürgerinnen und Bürger. Teilen und verbreiten hier der Link. Pobierz mp3 lub teledysk ULTRAMARIN - Weg von hier Official Video w najwyższej jakości.
Wir müssen weg hier. Und von hier aus betrachtet sehen die Dinge ziemlich gut aus. Hier twittert die Stadtverwaltung Ludwigshafen seit August 2013.
HttpsyoutubeEoimCbK3Fao dedo mnp meinnameprogramm. Denk daran alles wird gut. Listen to Ich Fliege by LISA 880 Shazams.
Ich muss weg weg weg weg. HttpamzntoMp3Taichi Facebook Seite liken.
Het gaat om één van de drie dochters van Ronald de Boer. De 24-jarige dochter van voormalig profvoetballer Ronald de Boer plaatste maandag een foto op.
Demi De Boer Is De Nieuwe Vriendin Van Ronnie Flex
De nieuwe vriendin van Ronnie Flex.
Nieuwe vriendin ronnie flex fotos. Ronnie Flex heeft al een tijdje een nieuwe vriendin namelijk Demi de Boer. De rapper deelt namelijk een kiekje met een dame op zijn Instagram en fans denken dat het zijn nieuwe vriendin. Demi heeft een Instagrampost geplaatst van haar en Ronnie Flex in een restaurant.
Famke is écht verleden tijd want Ronnies nieuwe schoonvader Ronald de Boer heeft aan Shownieuws bevestigd dat zijn dochter officieel aan het daten is met de rapper. We smelten compleet weg bij dit lieve koppeltje en zijn blij dat ze eindelijk Instagram official zijn. Dit is de nieuwe vriendin van Ronnie Flex en ze is HOT.
Het lijkt erop dat Ronnie Flex weer gelukkig is in de liefde. Ronnie heeft sinds zijn relatie met Famke-Louise die vorig jaar stukliep geen nieuwe relatie meer gehad. In december 2018 werd hij voor het eerst vader van dochter Nori.
Ik heb gemazzeld met Wef. Op Instagram is te zien dat Demi een foto heeft gedeeld van de twee samen. Ronald de Boer heeft aan RTL Boulevard laten weten dat zijn dochter een relatie heeft met rapper Ronnie Flex.
Op Instagram deelt de rapper namelijk een paar zoete kiekjes van een uitje. Demi neemt het voor haar vriend op en zegt dat social media niet de enige plek is waar Ronnie contact heeft met Bilal. Zijn nieuwe vriendin Demi de Boer heeft hun relatie Insta official gemaakt.
De girl krijgt meerdere felicitaties van vrienden en fans onder haar feed. De 27-jarige rapper Ronnie Flex heeft een nieuwe vriendin. De love birds zitten in een restaurant en de reacties onder de foto wijzen erop dat de twee samen zijn.
Yay Ronnie Flex heeft een nieuwe vriendin. Hoera voor de liefde. Demi de Boer deelt een lieve foto van de twee tortelduifjes op haar sociale media.
Demi de Boer deelde op haar Instagram een foto waarin Ronnie was te bewonderen op haar 24e verjaardag. Ronnie Flex heeft menig hart van zijn volgers laten smelten nadat hij een foto van hem en zijn dochtertje Nori deelde. Ronnie Flex 27 is gevallen voor de charmes van Demi de Boer.
Zó ziet de nieuwe bekende vriendin van Ronnie Flex eruit. In december 2018 werd hij voor het eerst vader van dochter Nori. Het verliefde stelletje Demi de Boer deelt op haar Instagram een foto van de twee samen.
Het is de dochter van voormalig profvoetballer Ronald de Boer. Voetballer Ronald de Boer de vader van Demi bevestigde aan RTL Boulevard dat zijn dochter op dit moment erg gelukkig is rapper Ronnie Flex. Deze relatie liep onder andere stuk omdat DJ Wef zwanger was van Ronnie.
Een andere vrouw had me misschien voor de rechter gesleept aldus de rapper. Dít is de nieuwe vriendin van Ronnie Flex. Deze foto is gemaakt op 23 februari de verjaardag van Demi.
De rapper deelt namelijk een kiekje met een dame op zijn Instagram en fans denken dat het zijn nieuwe vriendin is. Demi de Boer de nieuwe vriendin van Ronnie Flex plaatst een hele lieve foto op Instagram van hen samen. Ronnie Flex is sinds zijn relatie met Famke Louise in 2018 strandde een tijdje single geweest maar het lijkt erop dat hij nu toch opnieuw de liefde gevonden heeft.
Tadaaa om deze foto gaat het. De oud-voetballer heeft hem zelfs al een keer ontmoet. Een comment gaat viral waar wordt gezegd dat Ronnie zijn vriend had moeten supporten in plaats van niks van zich laten horen.
Op bovenstaande foto kwam veel kritiek waardoor Ronnie Flex de reacties heeft uitgezet. Ronnie Flex 27 vertelt in het winterboek van LINDAmeiden over zijn bijzondere band met de moeder van zijn dochtertje. Hij is namelijk aan het daten met de dochter van voormalig profvoetballer Ronald de Boer.
Ronald de Boer heeft aan Shownieuws laten weten dat hij de rapper wel een lieve jongen lijkt te vinden. Famke Louise en Ronnie Flex super intiem op de foto. Ze hebben elkaar helaas nog niet kunnen ontmoeten vanwege de coronacrisis.
Ronnie Flex. Ronnie heeft sinds zijn relatie met Famke-Louise die vorig jaar stukliep geen nieuwe relatie meer gehad. De vriendin van Ronnie Flex.
Ronnie Flex is sinds zijn relatie met Famke Louise in 2018 strandde een tijdje single geweest maar het lijkt erop dat hij nu toch opnieuw de liefde gevonden heeft. Vanaf dat moment gingen alle roddels natuurlijk rond. Maar onder de onderstaande video kan jij in ieder geval wél kennis maken met Demi de Boer.
Ronnie Flex is in love. Ronnie Flex. Deze relatie liep onder andere stuk omdat DJ Wef zwanger was van Ronnie.
Nieuwe vriendin van Ronnie Flex. Ze is niet alleen maar de dochter van want Demi lijkt het ondertussen. Op Instagram post Demi de Boer een foto samen met de rapper.
De twee gingen uit eten voor haar verjaardag. Volgens het onderschrift is de foto genomen op haar verjaardag op 23 februari.
Hij zegt in de video. Pas toen besefte ik ten volle hoe waardevol zon herdenkingsfilm wel kan zijn.
Nieuws Page 107 Of 1257 Parra Nieuws Hiphop Entertainment
Dit kreeg ik vandaag op een USB opgestuurd in me brievenbus.

Beelden tonen hoe lexxxus vrouw helpt video. Wanneer ik mensen zeg dat ik al die shit wat ik doe ook achter de schermen doe dan geloofd niemand me. Op de gepaste muziek kwamen de beelden helemaal tot hun recht. Achteraf heb ik een mooie bedankingsbrief in de bus gekregen.
Victor Schildkamp 26 mei 2021 Laatste update. Het lijkt er niet op dat de beelden in de video gemaakt zijn door één persoon. Nieuwe beelden tonen hoe gevallen BBC-icoon Jimmy Savile meisje bepotelt.
Cameras laten zien wat Lexxxus in zijn vrije tijd doet. Beelden tonen hoe bestuurder over voetganger rijdt op Champs-Élysées wagen in achteruit zet en nog eens op man inrijdt. Er zijn nieuwe beelden opgedoken van na de vliegtuigcrash afgelopen vrijdag op een autosnelweg in Orange County Californië.
De vakantie van een Tsjech in. Hij vindt het namelijk belangrijk om de komende tijd veel aandacht aan zijn gezin te besteden. Fascinerende beelden tonen hoe octopus zijn prooien voor de gek houdt Video.
De vrouw barst in tranen uit. Google has many special features to help you find exactly what youre looking for. In Joardy Sitcom VPRO speelt hij het personage Lexxxus.
Lexxxus gaf hem niet veel later de dag van zijn leven. Hallucinante beelden tonen hoe het er tijdens nieuwjaarsnacht aan toe ging in. Maar nu stopt hij.
De stemmen op de achtergrond van. Lexxxus vraagt zijn vrouw ten huwelijk VIDEO 15 February. Lexxxus liet via Instagram weten voorlopig te stoppen.
De beelden zijn op het officiële Instagram-account van Lexxxus geplaatst en tonen hoe de rapperentertainer vraagt of zijn vriendin met hem wil trouwen. De twee zijn al jaren samen en hebben kinderen maar nemen schijnbaar. Zijn overige zakelijke activiteiten vinden vooral plaats op.
The next video is starting stop. De video laat zien hoe verschi. Ik kan geen zak vol met.
Home Nieuws Gelekte beelden tonen hoe Lexxxus een vrouw helpt VIDEO Gelekte beelden tonen hoe Lexxxus een vrouw helpt VIDEO 5 July. Brazilië rondt trieste kaap van 450000 doden derde golf dreigt. Koning van de camouflage.
Rapper Lexxxus de Don Lionel Dors heeft namelijk samen met Joey Bravo oftewel Karwan Talei uit Almere kent u ook niet want is ook een rapper een dikke scam draaiende op. De video is uiteindelijk ruim vier minuten lang geworden. In deze beelden kan je zien dat hij helemaal niet is neergeschoten.
Op de beelden is te zien hoe de vrouw meebeweegt op het nummer The Style Week-End van Dance Glitch. Er is wat anders gebeurd met deze ganstah rapper hij heeft namelijk een. Een woordenwisseling tussen twee mannen is compleet uit de hand gelopen.
Zo was onder andere te zien hoe hij de boodschappen van een vrouw betaalde en verraste hij een Aziatische jongen die op virale beelden geslagen werd. Ontdek premium beelden met een. Lexxxus heeft gisteravond zijn vrouw ten huwelijk gevraagd.
De familie verliet zoals was afgesproken vlak voor het tonen van de beelden de rechtszaal. Search the worlds information including webpages images videos and more. Nu weten we wie er laatst op het huis van de rapper zonder vijanden heeft geschoten.
Lexxxus Nederland 1985 werd geboren als Lionel Dors. Beveiligingscamera beelden gelekt van Lexxxus die dit doet in een winkel. Bekijk deze stockfoto van Aziatische Chinese Midden Volwassen Vrouw Die Haar Vader In De Landbouwbedrijfkas Helpt.
Miljoenen Britten stemmen vanavond af op BBC2 voor een spraakmakende documentaire van Louis Theroux. Het universum is apart bezig met me. Akelige beelden tonen hoe meisje onder bed getrokken wordt door geest video Koen De Nef.
Een Filipijnse vrouw heeft een gênant momentje beleefd toen ze een TikTok-filmpje opnam. Er is wat anders gebeurd met deze ganstah rapper hij. Rapper Lexxxus de Don licht kinderen op maakt bizarre videos om iedereen uit te lachen.
Iedere vrijdag verschijnt een nieuwe aflevering op het YouTube-kanaal van Npo 3. Die herinnering hou je.
De conceptcar die de naam Mercedes-Benz Vision AVTR kreeg is geïnspireerd op diverse elementen uit de film maar komt niet in de film voor. Terwijl ik het zit in te tikken is dit zon beetje wat in mij opkomt.
Mercedes Benz Avtr Everything You Need To Know About James Cameron S Avatar Car Youtube
Eens in de zoveel tijd komt Mercedes weer met een conceptcar en dit keer staat echt iedereen even op zn kop.

Benz toont samenwerking avatar video. De nieuwe Citan is zoals bekend het gevolg van een samenwerking tussen het Duitse merk en Renault. Vandaag maakt Mercedes bekend dat de samenwerking flink wordt uitgebreid. Mercedes toont Avatar-auto met bewegende schubben.
De naam van dit baanbrekende conceptvoertuig staat niet alleen voor de nauwe samenwerking met het AVATAR-team tijdens de ontwikkeling maar ook voor ADVANCED VEHICLE TRANSFORMATION. Verder lezen over Mercedes-Benz Toys for boys. Mercedes-benz GLC43 AMG Mercedes AMG GT Black series pakt snelste tijd ooit op Nürburgring Nordschleife Mercedes.
De nieuwste conceptauto van Mercedes-Benz is ontwikkeld in samenwerking met Avatar-regisseur James Cameron. Het ontwerp voor de nieuwe flagshipstore is in nauw overleg met Mercedes-Benz en moederbedrijf Daimler AG tot stand gekomen mede om te zorgen dat de nieuwe corporate identity van het bedrijf Markenauftritt Retail MAR 2020 volledig tot zijn recht komt in het nieuwe gebouw. Sorteer op waardering Sorteer op datum nieuwste eerst Sorteer op naam A tot Z 500.
Het project vormt de pilot voor de uitrol van deze nieuwe huisstijl. Mercedes-Benz toont ongekend veel lef met hun nieuwe campagne Grow up Je zegt niet zo vaak Wow wat een campagne hier moet je wel lef voor hebben. Het ging daarbij om accus voor elektrische trucks.
23 december Nieuwe V6 dieselmotor bij Mercedes-Benz 20 december Mercedes-Benz toont nieuwe M-klasse 8 december Nieuwe V6 motor voor Mercedes-Benz E-klasse 27 oktober Jubileummodel voor 50-jarig bestaan Mercedes-Benz SL-klasse 24 oktober Volop aandacht voor milieu bij nieuwe Mercedes-Benz. Deze website werd gemaakt in samenwerking met volgende partners. Een Augmented Reality App wekt de auto op de stand tot leven zodat de bezoekers nog vóór de officiële wereldpremière tijdens de.
Mercedes-Benz lanceert een futuristische concept-car in samenwerking met de makers van de film Avatar Sony komt ineens met een heuse auto en Hyundai toont. Kennen we de door James Cameron geregisseerde film Avatar nog. De naam van de baanbrekende concept car staat niet alleen voor de nauwe samenwerking bij de ontwikkeling van de showcar met het AVATAR-team maar ook voor ADVANCED VEHICLE TRANSFORMATION.
FUTURISTISCH MERCEDES-BENZ TOONT VISION AVTR CONCEPT Momenteel is in Las Vegas gadget- en technologiebeurs Consumer Electronics Show CES aan de gang en het is dat jaarlijks terugkerende evenement waar Mercedes-Benz de Vision AVTR Concept heeft gepresenteerd. Mercedes breidt samenwerking met CATL uit. Videos bekijken opladen delen en bewerken.
Mercedes-Benz pakt uit tijdens North American International Auto Show. De EQS krijgt als eerste een accupakket van CATL. Door machielvdd op 05-08-2020 om 2133.
Door stekkerkoning op 14-05-2021 om 2216. Vijf indringende videos van Mercedes-Benz een van de belangrijkste au. Screencasting e-learning software.
Mercedes was eerder al in zee gegaan met Chinese accugigant CATL. Toont alle 9 resultaten 500. Het gaat goed met de bestellingen van de grote luxe elektrische Mercedes-Benz.
Toont alle 5 resultaten. Mercedes-Benz heeft namelijk een auto ontwikkeld die volledig is geïnspireerd door de film Avatar. De populairste klassieker van Nederland BMW en Mercedes in 2024 met zelfrijdende autos op de weg Mercedes-Benz EQC het begin van een nieuw tijdperk Dit zijn de Formule 1 wagens voor het seizoen 2019 Mercedes.
Het Duitse merk met de ster had al een klein belang in de Britse sportautofabrikant maar dat wordt nu flink uitgebreid naar twintig procent van de aandelen. Video delen Afbeelding delen. De productie van de Mercedes EQS is koud van start gegaan of er komen al ronkende berichten langs.
Mercedes-Benz onthult in Genève een bijzondere conceptcar die is gewijd aan de samenwerking met de makers van de Avatar-film. De sedan uit het luxesegment wordt geproduceerd in Factory 56 zoals. Mercedes-Benz VISION AVTR - geïnspireerd door AVATAR.
Mercedes-Benz toont samenwerking met Avatar VIDEO 7 January. De officiële introductie laat nog even op zich wachten maar Mercedes-Benz toont al een glimp van de nieuwe Citan op de BedrijfsautoRAI in Amsterdam. Zo werd onder meer de nieuwe C-Klasse in een bijzondere vorm getoond aan de bezoekers.
De overeenkomst heeft vooralsnog vooral invloed op de normale straatautos. Mercedes-Benz heeft diverse innovaties getoond tijdens de Consumer Electronics Show CES van 7 tot 10 januari 2014 in Las Vegas. Mercedes EQS kan rekenen op behoorlijke populariteit.
Op de Consumer Electronics Show in Las Vegas gaf regisseur James Cameron 65 voor het eerst beelden vrij van Avatar 2 het langverwachte vervolg op. Ondertussen zijn de eigenaren van het circuit druk bezig op in de toekomst een Grand Prix te organiseren. Dit conceptvoertuig belichaamt de visie van de Mercedes-Benz ontwerpers ingenieurs en trendonderzoekers inzake mobiliteit in de verre toekomst.
Red Bull Racing coureur Max Verstappen zal komend weekend te zien op het circuit van Zandvoort tijdens de Jumbo Racedagen. Mercedes-Benz krijgt een groter deel van Aston Martin in handen. 15 per pagina 30 per pagina alle tools.
De Duitse bondskanselier Angela Merkel en de Franse president Emmanuel Macron hebben vandaag een akkoord bereikt over de opvang van 400 niet-begeleide jongeren uit Moria op het Griekse eiland Lesbos. Toch spelen kinderen een kleine rol in de verspreiding van het nieuwe coronavirus.
Actualites Openbaar Ministerie
De brand geeft de urgentie aan om vluchtelingen te verspreiden naar het Griekse vasteland én naar andere Europese landen meent De Somer.
Toont hoe gevangen expres corona verspreiden om vrij komen video. In 2021 is het weer eens. De grafiek hieronder toont hoe de verschillende partijen dat willen aanpakken. Afgelopen week zijn er voor het eerst een handjevol coronabesmettingen bevestigd in de Jemenitische havenstad Aden.
De foto toont twee boas in. Speel het gratis Playitsafe Corona Preventie spel. Onze gevangenissen zitten overvol.
Gestemd dit zet geen zoden aan de dijk gevangen in je eigen keuzes. Hoe groter de afstand hoe kleiner de kans op besmetting. Zowel binnen als buiten de EU.
Een mooie aanleiding om het gesprek over deze zeer dodelijke ziekte aan te gaan. Niet enkel N-VA en Vlaams Belang maar ook CDV pleit daar nu duidelijk voor. Premier Aleksander De Croo geeft om 1700 uur een persconferentie over de beslissingen.
Wappie is een Nederlands scheldwoord voor mensen die de ernst van het coronavirus ontkennen daar valse informatie over verspreiden en daarom niet serieus genomen worden. Dit wordt beïnvloed door de duur van de besmettelijkheid van de. Er is grote kans dat het coronavirus zich ongemerkt al.
Speel het spel samen. RUG en Hanze-studenten die zich hebben ingeschreven voor een fysiek tentamen worden uitgenodigd om. Aanvoerder maakte eerst tong vrij van Eriksen en troostte nadien huilende echtgenote 8-jarige jongen verdronken in Erpe-Mere tijdens wedstrijd Rode.
Een smoes verzinnen om onder een verplichting uit te komen. Nieuwsfotograaf Arie Kievit beraadt zich op juridische stappen nu er een foto van hem wordt misbruikt voor het verspreiden van fake news op Facebook. We zien een stijgend aantal infecties bij alle leeftijden.
Misschien leer je zelf ook nog iets bij. Dit komt doordat de grotere druppels niet zo ver komen. De besmettingen en besmettelijkheid van kinderen neemt wel toe als ze ouder worden.
Fá yo set éng now. Onder pres Venetiaan heeft het circa 10jr geduurd om de koers te stabiliseren naar 1 op 3 en dit na een destructieve ndp regering. Do 23 apr 1455.
Het gele boekje is een stuk veiliger en makkelijker. Maar we hebben te maken met een elite familietraditie die massale ontvolking ziet als een doel over meerdere generaties en die niet te stoppen is om macht te krijgen en te behouden. Lees daaronder de voorstellen van alle partijen.
VIER Op 13 maart 2020 in volle draaiperiode voor het tweede seizoen van Ooit Vrij barstte. De Centrale Toezichtsraad stelt daarom voor om in deze coronatijden alle gevangenen vrij te laten die kunnen vrijgelaten worden. Groningen is de eerste stad in Nederland die zon pilot gaat doen.
Dat toont een rondvraag van VRT NWS. Tsja moeilijk hoor 2035 dan ben je waarschijnlijk ver boven de 80. En de kleinste druppels verdunnen over een grotere afstand.
1918Een mensensmokkelaar die migranten verstopte in sofas is veroordeeld tot een gevangenisstraf van twee jaar en zeven maanden. Er zijn nu meerdere systemen om te bewijzen dat je geen Corona hebt of gevaccineerd bent. Aloy heeft hem op pad gestuurd maar hij wordt gevangen genomen door.
In 5 minuten komen alle voorzorgsmaatregelen langs. Video De coronacrisis brengt veel angst stress en zorgen met zich mee maar sommige dingen worden juist een stuk makkelijker. Tijdens de coronacrisis botste het beleid vaak op de complexe organisatie van de zorg.
Deze persoon gebruikt de. Benadruk dat het NIET naleven van de regels grote gevolgen kan hebben voor de gezondheid van opas omas ooms en tantes en andere dierbaren. Seizoen 2 is elke maandag om 2035 uur te zien op VIER.
COVID-19 komt minder vaak voor bij kinderen en ze verspreiden het virus minder. In de video is ook het personage Erend uit Horizon Zero Dawn te zien is. Het vermeende bewapende virus is slechts het laatste excuus.
13 januari - Om te onderzoeken hoe op termijn meer fysiek onderwijs mogelijk is in coronatijd starten de Rijksuniversiteit Groningen RUG Hanzehogeschool Groningen en Noorderpoort vanaf maandag 18 januari een pilot met een sneltestlocatie op de Zernike Campus. Speel het spel via onderstaande link. Daarnaast heb je op Syllie S.
Verspreiding van het virus vindt. Ik moet erachter komen hoe ik de vaccintoxines radionaal kan extraheren wanneer ze de systemen binnenkomen. Kjaer als held.
De volgende dia toont hoe het virus zich kan verspreiden door contacten tussen mensen. Bekijk de video Hoe groter de afstand hoe kleiner de kans op besmetting De kans dat je besmet raakt is het grootst als je dichtbij iemand met het coronavirus bent. Ook bij jongeren en jongvolwassenen.
Ook een goede luchtverversing draagt. De 21-jarige man probeerde om de migranten in het Verenigd.
Jayden deelt hierover een grappig verhaal op TikTok want een collega van zijn moeder vond hun kinderen dus wel bij elkaar passen. Er circuleren vandaag heel wat gekke challenges op het internet.
Moeder Tiktok Gebruiker Stort Door Plafond Terwijl Dochter Filmpje Opneemt Video Panorama
Moet ik hierover praten met mijn kind.

Reageert op tiktoks van zijn dochter we gaan hierover praten video. Gwendolyn Portzky directeur van het Expertisecentrum Suïcidepreventie roept intussen op om de beelden niet door te sturen. De videos zijn bedoeld om in maximaal 1 minuut iets leuks te laten zien. 2 Je reageert op een video van een ander en door op elkaars comments te reageren krijg je ook een soort groepschat.
Door de acties op het gebied van handhaving uit te leggen en tegelijkertijd mensen het ons beleid te herinneren is het aantal herhaalde. Ons jongerenmagazine Karrewiet sprak met kinderen die al nare ervaringen hadden op TikTok. Nochtans werkt TikTok met sterke AI-systemen.
Er zijn weinig volwassenen op TikTok om een oogje in het zeil te houden en de volwassenen die er wel gebruik van maken hebben soms foute bedoelingen. Binnen Nederland zijn er ruim 1 miljoen gebruikers waarvan ongeveer 850000 gebruikers tussen de 6 en 18 jaar oud. Zelfdoding op TikTok choqueert gebruikers.
Als je elke keer op elkaars videos reageert ontstaat er een soort groep. Maar dat liep even anders dan gepland. De resultaten zijn volgens TikTok veelbelovend.
Hij deelde zijn video eerst tijdens een Facebook-livestream maar al snel kwam het filmpje op TikTok terecht. De man livestreamde zijn zelfmoord vorige maand op. Ze eisen naar eigen zeggen meer dan een miljard euro voor.
Vooral tieners houden ervan om zulke uitdagingen aan te gaan en het resultaat op social media te. Op het socialemediaplatform TikTok circuleert al een aantal dagen een video van een Amerikaanse man die zichzelf van het leven berooft. Stop met de video te delen.
Op het socialemediaplatform TikTok circuleert al een aantal dagen een video van een Amerikaanse man die zichzelf van het leven berooft. Jayden moest het ff kwijt op TikTok. Ik was daar echt wel een beetje bang voor want wie kan dat zijn alles kan gebeuren vertelt één van de kinderen.
In principe is het concept achter TikTok heel onschuldig. In deze video ga ik reageren op tiktoks Veel kijkplezier vergeet niet met de volgen en mijn videos liken. Om te zorgen dat je kinderen TikTok veilig kunnen gebruiken raden we je aan op zijn minst te weten hoe het werkt.
Het platform dat vooral populair is bij kinderen en jongeren zegt dat het er alles aan doet om de video weg te halen. Daar is het nu viraal gegaan. Gebruikers worden uitgedaagd creatief aan de slag te gaan door het maken van videos.
Ze hebben het over anonieme mensen die hen berichtjes stuurden of vroegen om af te spreken. De Chinese makers van de app beloven nu alle videos van Amerikaanse gebruikers die jonger zijn dan 13 te verwijderen. De socialemedia-app TikTok probeert momenteel een extreem schokkende video te verwijderen waarin te zien is hoe een man zichzelf doodschiet.
1 Je maakt een video gericht aan de mensen waar je een groep mee wil vormen zodat zij weer een video-antwoord kunnen maken op jouw video. Van een ijskoude emmer water over je heen gieten Ice Bucket Challenge tot stokstijf stilstaan als een etalagepop Mannequin Challenge. Mensen gaan stuk om het einde van de video.
Hoe jij omgaat met voorgeschotelde videos kijkduur interactie en zelfs de beweging van je telefoon bepaalt welke videos in jouw feed verschijnen. Nieuwe functies moeten het voor ouders makkelijker maken om het gebruik van de populaire video-app TikTok door hun kinderen in te perken. TikTok is een social media platform gebaseerd op audio en video.
Ook moet voortaan duidelijk toestemming van de ouders worden gevraagd voor. TikTok springt dit jaar van de zestiende naar de vierde plek in de lijst met populairste apps en begint zelfs een bedreiging te vormen voor titanen als Facebook en Instagram. Ten eerste zijn de videos die je te zien krijgt als gebruiker gebaseerd op machine learning.
Bijvoorbeeld aan een dochter van een collega of aan een buurjongen. Videos en gebruikers rapporteren of blokkeren Net zoals bij andere sociale media wordt TikTok soms gebruikt om te cyberpesten of dingen te tonen die niet geschikt zijn voor je kinderen. Een groep van 64000 Nederlandse ouders heeft een schadeclaim ingediend tegen het bedrijf achter socialemedia-app TikTok.
Een anoniem mens heeft naar mij iets gestuurd.
BARZ4DAYZ PART 1 Lyrics. 27 01 OVERAL BESCHIKBAAR.
Kingsize Barz4dayz Part 1 Prod Teekay By User 9182960
The company was named TK for Karlshoejs initials.

Barz4dayz part 1 prod teekay. By Teekay Instrumental OUT NOW. Latest high quality audio Kingsize - BARZ4DAYZ PART 1 - Mp3 Download TikTok video Android iPhone Rigntones WhatsApp Instagram Facebook status download for free. KINGSIZE - BARZ4DAYZ PART 2 PROD.
Kingsize - Barz4dayz Part 3 Prod. Swipe up via onze story naar de video. ABONNEER NU OP ONS KANAALStream enof download BARZ4DAYZ PART 2 inclusief de instrumentalLink.
Total 0 Shares Share 8 Tweet 0 Pin it 0 Share 0. By Teekay video by byrez OUT NOW. BEKIJK HIER DE VIDEO.
By simply butting two pipes together and connecting with a Teekay Pipe Coupling space weight time and cost savings are achieved with every installation. Teekay by Wilde Westen and see the artwork lyrics and similar artists. Teekay Tankers Ltd.
Teekay Pipe Couplings allow pipes to be joined without the need for flanging grooving threading or welding. As part of global group rebranding initiative March 24 2020 0400 ET Source. Op een beat van Teekay horen we keiharde bars van de Wilde Westen member.
Read about Kingsize - BARZ4DAYZ PART 1 Prod. Kingsize x Hmizo x Boegie x CT Greuyy - Avondklok prod. Het was een lange radiostilte rondom de Haagse rapper Kingsize maar vandaag is hij eindelijk weer terug met nieuwe muziek.
And adjusted net loss 1 of 220 million or 065 per share in the first quarter of 2021 excluding items listed in Appendix A to this release. Als rappers rappen hoe ik ap hebben ze 5 schrijvers Ik doe dit niet voor kijkcijfers maar voor eindcijfers Alsof ik afstudeer mn domme shit niet afgeleerd Ik. Home Videoclips Kingsize Barz4dayz Part 5 Prod.
March 27 2020. KINGSIZE BARZ4DAYZ PART 2 PROD. Reported GAAP net loss of 214 million or 063 per share.
ABONNEER NU OP ONS KANAALStream enof download BARZ4DAYZ PART 5 inclusief de instrumentalLink. Teekay Offshore Partners LP. Problemchild Kingsize - Barz4dayz Part 1 prod.
VANCOUVER British Columbia March 27 2020 GLOBE NEWSWIRE Teekay Corporation Teekay NYSETK today announced that it has entered into a new bareboat charter contract with the Foinaven Operator Britoil Limited a subsidiary of BP plc for the Petrojarl Foinaven Foinaven floating production storage and offloading FPSO unit for up to approximately. Teekay Kingsize dropt Avondklok P2 brengt Trap Baby TT dropt Gliden Orlando KS Verleden Tijd. Aan ALLE talenten en artiesten.
Kingsize trapt zijn Barz4Dayz seizoen af met part 1 prod. Later vandaag ook de video. Teekay LNG Partners LP.
Teekay was founded in 1973 by Torben Karlshoej then a 31 year old Danish ship broker who had emigrated to the United States at the age of 20 and mostly worked on farms. It commenced operations by purchasing small second and third hand oil tankers a lucrative trade due to the high oil prices. Reports First Quarter 2021 Results.
Kingsize - BARZ4DAYZ PART 1 Prod. Kingsize Barz4Dayz Part 1 Prod. Kingsize - Barz4Dayz part 1 prod.
Teekay Offshore Partners LP. Changes its name to Altera Infrastructure LP. As part of further reducing Teekay Tankers cost of.
Teekay Kingsize Barz4dayz Part 5 Prod. Hij dropt vandaag zijn Barz4Dayz part 1 track. Kingsize - Barz4Dayz part 1 prod.
Teekay has developed from a regional shipping company into one of the worlds largest marine energy transportation storage production companies. Teekay Wilde Westen - Wij gaan de mensen trapologie geven.
If you mounted a motorized device on a linear straight track and placed each snap-action switch on opposite ends of the track you could throw the switch in one direction and the device would automatically stop when it reached the end of the track. How to make forward and reverse switch for DC MotorMaterials and buy links6Pin Rocker Switch.
Video Chivv X Km Switch Sides Prod Reverse
If the user throws the lever into the opposite direction the other snap-action switch is not being pressed against and so it allows the motor to reverse.

Km switch sides prod reverse. What is a Reverse KVM Splitter. A reverse KVM allows the connection of multiple KVM consoles independent keyboard video monitor mouse setups to a single computer. 110 volt cord and cord cap are 57 long.
Then using a SPST switch or some other control circuit you. Very nice running bolt on installation. Freedom II Rackmount Kit for 1 unit in 1U for Freedom II KM 4-Port Switch - KV0004A-R2.
Freedom II Rackmount Kit for 1 unit in 1U for Freedom II KM 4-Port Switch - KV0004A-R2. Motor has a 25 metal armored cord from motor to Square D forward and reverse switch. In this video I show how you can have a DC motor turn one direction until it hits a limit switch.
While I have the bike apart for my clutch repair I thought that I could simplify my connections by leaving out this extra switch and hook up the pilot current grounding for my own reversing gadget relays to the bike wires. 54 product ratings - DC Momentary Motor polarity reverse reversing Rocker switch control DPDT 12v. The AVP4 is ideal for video splitting resource sharing and KVM matrix applications.
Reverse KVM Switches allow more than one user to acces the same computer AVP2-UK AVP4-UK we sold our first KVM switch in 1988. How to control the motor forward reversal with two micro switches. Bolt mounting pattern is 3 58 to 6 18 front to back slot.
Rackmount kit for your Freedom II KM Switches. With only one keyboard and mouse required to operate four computer systems desk space can be made more ergonomically effective and the time it takes for operators to access multiple computers and view multiple displays at the same time is reduced. This technology is great if you were looking for access to a single computer from a different room or wanted to share the same information on two different screens for a presentation or even for training.
About Press Copyright Contact us Creators Advertise Developers Terms Privacy Policy Safety How YouTube works Test new features Press Copyright Contact us Creators. Hello everyone today i going to show you How to make a reverse switchif you have any questions leave a comment below materials neededtwo normal switches or. Today 70 of our sales remain offline to Systems Integrators Corporates and Government.
Motor shaft is 2 long. 58 diameter with keyway. KM Switches Switch between computers simply by moving a mouse cursor from monitor to monitor.
3 side to side on center. There are two common sources of reverse voltage. Pricing is for US.
Reverse Current Protection in Load Switches 1 Sources of Reverse Current Reverse current is when there is a higher voltage at the output of a system than at the input causing current to flow backwards through the system. USB 8-Port Switch USB Sharing Switch Synchronous Controller with 8 Cable Sets 1 KM Control 8 ComputersOne-Button Swapping for WindowsLinuxUnixDosNetware System. International pricing will vary.
If playback doesnt begin shortly try restarting your device. As I have some reversing related gadgets added to my bike reversing lights leds reversing buzzer and radar I have added an extra microswitch in the reverse knob shaft. The AdderView Prism AVP4 is a 4-port reverse KVM switch that enables up to four consoles to access a single computer or KVM switch.
C 1955 15 off. Reverse Light Switch For HYUNDAI Accent Kia 93860-39000 93860-39001 93860-39002.
Justin Bieber maakt korte metten met de beschuldigingen van verkrachting. Justin Bieber wint eerste ronde in verkrachtingszaak.
Justin Bieber Eist 10 Miljoen Van Beschuldigers Misbruik Rtl Boulevard
Op dat moment was hij in Austin Texas samen met zijn toenmalige vriendin Selena GomezJustin reageert op de geruchten en ontkent alles.

Bieber aangeklaagd verkrachting reageert op beschuldigingen video. Marilyn Manson reageert op beschuldigingen misbruik. Twee vrouwen zijn naar voren gekomen om Justin Bieber 26 te beschuldigen van seksueel misbruik. Justin Bieber reageert op vermeende verkrachtingszaak.
Justin Bieber is recent beschuldigd van verkrachting. Celebrities Twitter moet de identiteit bekendmaken van de twee vrouwen die Justin Bieber 26 online beschuldigd hebben van verkrachting. De rechter heeft bepaald dat Twitter de identiteiten moet vrijgeven van de twee vrouwen die Justin Bieber beschuldigen van verkrachting meldt NBC.
Justin zelf heeft inmiddels gereageerd op de aantijgingen. Zij in haar vriendinnen werd gevraagd om te wachten op de zanger zodat ze hem. Dat geld wil hij ontvangen van Danielle en Kadi de twee vrouwen die de aantijgingen naar buiten brachten.
Hij zegt op Twitter dat hij normaal nooit reageert op dit soort geruchten maar omdat hij vindt dat seksueel misbruik altijd serieus genomen moet worden wil hij toch zijn kant laten horen. Danielle zegt dat beschuldigingen aan het adres van Ansel Elgort haar ertoe hebben gebracht naar buiten te treden. Justin Bieber laat het er niet bij zitten dat twee vrouwen hem hebben beschuldigd van verkrachting.
Dat zou zijn gebeurd na een evenement in. Justin Bieber is deze week door twee vrouwen beschuldigd van ernstige feiten. Justin Bieber beschuldigd van verkrachting.
De eerste vrouw genaamd Danielle claimt dat zij in maart 2014 naar een evenement in Austin Texas was waar Bieber moest optreden. Nadat hij eerder al aankondigde 10 miljoen dollar van beide meiden te eisen komt hij vandaag met - volgens eigen zeggen - onomstotelijk bewijs dat hem vrij moet pleiten. Er wordt beweerd dat de zanger in 2014 een vrouw seksueel misbruikt heeft.
Valse beschuldigingen brengen enorme schade toe aan mensen die écht slachtoffer zijn geworden van seksueel misbruik Lili reageert op een tweet van haar ex Cole en zegt. Twee vrouwen hebben superster Justin Bieber beschuldigd van seksueel misbruik. Hij eist volgens Amerikaanse media 20 miljoen dollar.
Volgens de zanger is dit verhaal absoluut niet waar en om dat te bewijzen heeft Bieber meerdere screenshots op sociale media. Justin Bieber is helemaal klaar met de roddelverhalen waarin beweerd wordt dat hij in maart 2014 een vrouw verkracht zou hebben toen hij in Austin Texas was. De acteur is beschuldigd van het seksueel misbruiken van de toen 17-jarige Gabby in 2014.
De zanger onderneemt stappen en gaat naar de rechter. Justin Bieber werd afgelopen weekend beschuldigd van seksueel misbruik. Ik heb beschuldigingen van aanranding altijd serieus genomen.
Justin Bieber is helemaal klaar met de roddelverhalen waarin beweerd wordt dat hij in maart 2014 een vrouw verkracht zou hebben toen hij in Austin Texas was. Beschuldiging De eerste vrouw Danielle zegt in 2014 te zijn verkracht door Justin Bieber. Video In brief Amalia zit deze hint verborgen.
Twee vrouwen beweren dat zij door Justin Bieber zijn misbruikt. De feiten zouden dateren van 2014 maar Bieber en zn label ontkennen dat er toen. Dit zou na afloop.
Twee vrouwen zijn naar voren gekomen om Justin Bieber te beschuldigen van seksueel misbruik. Volgens het nieuwsplatform ontkent het kamp van de zanger één van de beschuldigingen als feitelijk onmogelijk. Ze beschuldigen de popster ervan dat hij hen seksueel zou hebben misbruikt.
Justin Bieber doet een broekje open over zijn seksleven Onmogelijk Justin heeft nu zelf ook gereageerd op de beschuldigingen. Het is bewezen dat dit account speciaal is gemaakt om valse verhalen over mij en de rest van de cast te. De eerste vrouw die zichzelf Danielle noemt zegt in 2014 verkracht te zijn door de zanger.
Justin Bieber stapt naar de rechter nadat twee vrouwen hem de afgelopen dagen hebben beschuldigd van van verkrachting. Volgens de zanger is. Justin Bieber beschuldigd van verkrachting.
Volgens de website Too Fab ontkent het kamp van de zanger een van de beschuldigingen als feitelijk onmogelijk. Justin Bieber beschuldigd van verkrachting zanger reageert direct. Justin Bieber eist 20 miljoen dollar van de twee jonge vrouwen die hem vorige week hebben beschuldigd van seksueel misbruik.
Volgens de website Too Fab noemt het kamp van de zanger een van de beschuldigingen. De eerste vrouw die zichzelf Danielle noemt zegt in 2014 verkracht te zijn door Bieber. Een andere vrouw antwoordde op de tweet met Danielles verhaal dat ze ook is verkracht door Bieber.
Volgens de website Too Fab ontkent het kamp van. De zanger eist 20 miljoen dollar van de twee vrouwen. Marilyn Manson opnieuw aangeklaagd voor verkrachting.
De 22-jarige socialite is uit de kleren gegaan voor Playboy en de eerste fotos zijn gedeeld. Sierra Egans passie voor showbizz dateert uithaar jeugdjaren.
Kendall Jenner Lengte Leeftijd Vriend Familie Biografie En Meer
Ze is op 9 juni 1997 geboren in Californië.

Jenner leeftijd playboy afkomst vermogen relatie. Het meest dat ze heeft onthuld is dat ze een gemengde etniciteit heeft bestaande uit Italiaanse en Indiaanse afkomst. In 2019 was Kylie Jenner benoemd tot de jongste miljardair van de wereld. Kendall Jenner haar sterrenbeeld is.
In maart 2019 is het officieel. De 22-jarige spreekt vrijdag op Twitter de beschuldigingen tegen van. Ook stond Kylie Jenner onlangs met haar ex-vriend Travis Scott op de cover van de Playboy.
De tv-persoonlijkheid is anno 2021 bekend van Keeping Up With the Kardashians. Jaden Christopher Syre Smith geboren te Los Angeles California USA. Het is niet de eerste keer dat het stel - dat sinds 2014 samen is - op vakantie is in Las Vegas.
Koningin Laitfah is 49 jaar en bezit een netto vermogen van 60 miljoen Latifah lijkt zich niet echt druk te maken om haar relatief hoge leeftijd voor het moederschap. Andre Hazes post naaktfoto vriendin. Ben is van joodse afkomst.
Kylie Jenner 22 zal vanaf 17 september samen met haar vriend Travis Scott te zien zijn in de Playboy. Zijn ouders migreerden gedeeltelijk van Rusland naar de Verenigde Staten. Kendall Jenner leeftijd Kendall Jenner.
Wie de vader van het. Ze is daar opgegroeid samen met haar oudere zus Alexia. De 14-jarige jongen uit Lunteren die heeft bekend zijn klasgenoot Romy Nieuwburg 14 uit Hoevelaken te hebben verkracht en vermoord raakte na zijn daad geen moment in paniek Nieuwe lichaam accepteren.
Sterren het zijn net mensen. In 2020 is haar vermogen vastgesteld op 12 miljard dollar. Hij werd geboren als Ben Aaron Shapiro op 15 januari 1984 in Los Angeles Californië waar hij zijn hele jeugd doorbracht.
Shapiro ging naar Walter Reed Middle School envervolg op Yeshiva University High School van Los Angeles. En zeker met het vertekende beeld dat door Kylie Jenner en haar zussen op Instagram geschept wordt is het fijn om af en toe te beseffen dat zij soms gewoon dezelfde. De acteur is anno 2021 bekend van The Karate Kid.
Ze was toen zestig jaar oud waardoor ze het oudste model ter wereld was dat ooit met een blootreportage in Playboy stond. Samen met zijn professionele leven met miljarden fans in de buurt was hij in het verleden niet gelukkig met zijn persoonlijke leven. Halfzus Kim Kardashian ging haar in 2007 al voor nu is het de beurt aan Kylie Jenner.
Daarmee is ze de rijkste van the Kardashians. Privéleven en moederschap Kylie Jenner had drie jaar een relatie. Op 8-7-1998 is Jaden Smith bijnaam.
En het is óók niet de eerste keer dat André zijn vriendin. Kylie Jenner is op 21-jarige leeftijd de jongste miljardair ooit en verbreekt daarmee het record van Facebook-oprichter Mark Zuckerberg die op 23-jarige leeftijd zich tot de allerrijksten mocht rekenen. Dat is in de handen van God zegt ze tegen het Amerikaanse Parade Magazine.
Hij heeft halflang bruin haar en blauwe ogen is 5 ft 10 inch 179 m lang en weegt ongeveer 156 lbs 71 kg - zijn netto waarde is. Kylie Kristen Jenner is geboren op 10 augustus 1997. Kenny geboren te Los Angeles CA UAS.
Kylie Jenner in de Playboy. In 2020 is haar vermogen vastgesteld op 12 miljard dollar. Relatie vermogen lengte tattoo afkomst.
Daarmee is ze de rijkste van the Kardashians. Relatie vermogen lengte tattoo afkomst 2021 - Taddlr. Eind 2009 werd een fotoreportage van haar gepubliceerd in de Nederlandse editie van het mannenblad Playboy.
Op 3-11-1995 is Kendall Jenner bijnaam. Haar vermogen wordt geschat op 4. Kylie Jenner in de Playboy.
Gepost door Antje Utgaard Aan Woensdag 25 september 2019 Haar contracten en projecten hebben haar geholpen inkomsten te genereren en tegelijkertijd voordelen te bieden zoals reizen. Alaina Marie Mathers is de bekende naam die bij ons bekend is omdat zij de dochter is die geadopteerd is door de rapper van Amerika Eminem Het persoonlijke leven van Eminem zit vol met complicaties en complexiteiten. AMSTERDAM - Romy Monteiro heeft haar relatie met haar verloofde Django van Rijn verbroken.
Jaden Smith zijn sterrenbeeld is Kreeft en hij is nu 22 jaar oud. Kimberly Noel Kardashian Los Angeles 21 oktober 1980 is een Amerikaanse televisiepersoonlijkheid. Stassie Baby is van Griekse afkomst en woont nu nogsteeds in de Verenigde Staten.
Het was haar derde fotoreportage. Ze heeft op dit moment een relatie met Noah Centineo bekend als acteur. Relatie vermogen lengte tattoo afkomst.
Uiterlijk en vermogen Landon is 28 jaar oud. Antje Utgaard heeft een vermogen van naar schatting meer dan 400000 grotendeels verdiend door succes in het modelleren. Hollywoods new sex star takes it all off prijkt op de cover van het kerstnummer van de.
Sinds 2007 neemt ze deel aan de realityserie Keeping Up with the Kardashians waarin het dagelijks leven van Kardashian en haar directe familie wordt gevolgd de spil van het commerciële imperium van de familie Kardashian. Zij gaat haar zus Kim Kardashian achterna en deelt op Instagram alvast een voorproefje van. Als jongere hield ze van verschillende vormen van dansen en maakte ze van elke gelegenheid gebruik om haar talent te.
Ook stond Kylie Jenner onlangs met haar ex-vriend Travis Scott op de cover van de Playboy Kylie Jenner heeft niet valsgespeeld voor een plek op de selfmade miljardairslijst van Forbes. Kylie Jenner uit de kleren voor shoot in Playboy. Op Instagram meldt Romy dat ze met veel liefde voor elkaar hebben besloten om hun verloving en relatie.
Tijdens mijn studie leerde ik een aantal mensen kennen waaronder een meisje. Tik op het startscherm op de klok houd deze even vast en til vervolgens uw vinger op.
Stel de datum en tijd van de cameraklok in door SnapBridge 360170 M tab c Camera M Camera-instellingen M Datum en tijd te selecteren.

Wil op date model wordt keihard afgewezen beelden. Nieuwsredacties gaan meestal op zoek naar een beeld dat opvallend is een eye-catcher dat mensen nieuwsgierig maakt. Een klok verplaatsen of verwijderen. Het beeld dat gekozen wordt bij een nieuwsitem.
Op dit moment date ik niet echt bepaald veel maar dit wil niet zeggen dat ik er niet over nadenk. De date was niet echt voor het plezier maar meer een moetje. Tik op de klok op het startscherm en houd deze vast.
Het weekblad Die Zeit publiceert en serie over waarheid en propaganda. We wisten al dat er een reboot van de Nickelodeon-serie aan zat te komen maar nu is ook de trailer de wereld in geslingerd. Ze roepen bepaalde associaties op.
Wil jij nou als nog graag gegrimeerd worden stuur gerust een berichtje er. Het drietal is goed opgedroogd. En dan is het carnaval.
De politie ontdekte deze week een huis in Assen dat vol met honden- en kattenpoep lag. Vorig jaar had ik een date en toen leerde ik mezelf echt heel goed kennen. Hoe beelden in de media kunnen liegen en bedriegen.
Het lichaam van het model was digitaal aangepast. Tik op de blokjes en versleep deze om het formaat van de klok aan te passen. Het is pure nostalgie.
Taal wordt verwacht en ze beelden in taal moeten omzetten. Sterker nog een levendig liefdes- en seksleven betekent vaak dat je veel meer wordt afgewezen. Beelden vertellen een eigen verhaal.
De meerderheid 76 gaf de voorkeur aan de natuurlijke of licht geretoucheerde fotos in plaats van de zwaar ge-airbrushte fotos. Nederland SBN wil beelddenken onder de aandacht brengen van het onderwijsbeleid en van de onderwijspraktijk. Maar beelden zijn er niet enkel om het nieuws aantrekkelijker te maken.
Voor gerichte beelden is steeds toestemming nodig. Kreeft wil graag het hof gemaakt worden tijdens een eerste date. Grond van de aangeboden visuele informatie een beeld op over een voorwerp proces of begrip.
January 9 2020 Bijna carnaval. Voor DNR geeft Anneke van Ammelrooy een samenvatting van elke aflevering. De tortelduifjes genieten van een romantische lunch in een park waar olifanten worden opgevangen die in gevangenschap hebben geleefd.
En één ding is duidelijk. De bewoonster verwaarloosde zichzelf en haar huisdieren. Niet gerichte beelden.
Waarom worden beelden gebruikt. Er worden nu rondom de klok witte blokjes weergegeven waarmee u het formaat kunt aanpassen. Op jonge leeftijd hebben immers ouders nog de grootste invloed op hun kinderen maar in de periode van de vroege adolescentie gaan kinderen op zoek naar zelfstandigheid waardoor ze meer vatbaar worden voor invloeden van buitenshuis om definitie te geven aan.
In deze les zitten 48 slides met interactieve quizzen en tekstslides. De iconische serie iCarly met daarin onder anderen Carly broer Spencer en goede vriend Freddie. Voor een plezierig seks- en liefdesleven hoef je niet te streven naar 100 controle.
Kreeft vrouw moet eerst iemand voor honderd procent vertrouwen voordat ze zich gewonnen geeft. Beeldredacties hebben het tegenwoordig maar moeilijk. Journalisten hoeven geen toestemming te vragen als deze beelden gebruikt worden in het kader van nieuwsverslaggeving.
Op dat moment denken in begrippen cq. Examen Nederlands 2016 TV1. De cameraklok is niet zo nauwkeurig als gebruikelijke horloges.
4 TL Examen Nederlands 2016 TV1. Nederlands Middelbare school vmbo g t Leerjaar 4. Hoe beelden in de media en op internet vaak keihard liegen.
In de teaser krijgen we alvast een voorproefje van de date van Kasper en bachelorette Gaby die letterlijk én figuurlijk in het water valt. Wanneer de camera voor de eerste keer wordt ingeschakeld staat de cameraklok op 01012017 0000. Het Dove Global Beauty and Confidence Report 2016 concludeerde dat 7 van de 10 69 vrouwen en 6 van de 10 65 meisjes vindt dat er in de media een.
Ik wil duidelijk maken dat het normaal is dat je wel eens wordt afgewezen. Een Kreeft daten eist veel geduld. Dat is te zien op de eerste beelden van aflevering zes.
We sturen je zo snel mogelijk een berichtje om een datum te prikken. Oh en we kunnen niet wachten. Alles kan stuur pb voor info.
Datum en tijd van de opname zijn onjuist. Geen toestemming nodig om de foto te nemen Niet gerichte beelden die niet de intentie hebben bepaalde personen duidelijk in beeld te. Je kunt niet alles volledig zelf in de hand houden.
Omdat ze kieskeurig is is het is voor haar date moeilijk in te schatten of hij of zij het goed doet.
Sla ze op in SRT-formaat kies uit meer dan 50 talen. Weather forecast videos created by the Met Office.
Y2meta Downloader Download Youtube Video Convert Youtube To Mp3
What is Google Meet.

Met youtube video 10. YouTube Video Converter Convert YouTube FLV MP4 to MP3 AVI MPEG MP4 3GP MKV and other formats or convert YouTube videos to be compatible with iPhoneiPad iPod Apple TV Galaxy HTC One Moto X Nexus Kindle Surface Lumia and other devices. MET TOP 40 CHART. BSPlayer is used by more than 70 million multi media users throughout the world and it has been translated into more than 90 languages worldwide.
Als u de instellingen voor het afspelen van video wilt openen selecteert u Start Instellingen Apps Video afspelen. In Movavi Video Editor Plus is elke tool precies op de goede plek. Before 2017 YouTube Video Editor was the best editor for all YouTubers but then Google announced that only people having more than 100000 views on their videos could save the changes they made.
Open de mobiele YouTube-app. Willie Sellmore takes a jab at the previous speaker saying their speech made 10 minutes seem like an eternity. 10 Best Video Editors for YouTube in 2020 Edit YouTube Videos Easily.
DVDVideoSoft video downloader detects all video versions YouTube offers even if its the newest 8K stream. Zo verifieer je je Google-account. Voor deze apps kunt u het afspelen van videos regelen met behulp van de video-afspeelinstellingen van Windows 10.
Enjoy the videos and music you love upload original content and share it all with friends family and the world on YouTube. Dus zelfs als je nog nooit hebt geprobeerd om op een pc video te bewerken video bewerken met dit programma duurt. Zie Problemen met slechte videoweergave oplossen als u problemen heeft met het afspelen van video.
Met een geverifieerd account kun je videos uploaden die langer zijn dan vijftien minuten. Hangouts Meet and Hangouts Chat were rebranded to Google Meet and Google Chat in April 2020. Using your browser share your video desktop and presentations with teammates and customers.
Everything you need to know about the forecast and making the most of the weather. Watch 10 years 4 million YouTube followers meet the internets favourite mad scientist 04 - Too48890 on Dailymotion. Using your browser share your video desktop and presentations with teammates and customers.
Search millions of videos from across the web. Tik op Opnemen of selecteer een video die langer is dan 15 minuten. Real-time meetings by Google.
Haal ondertitels uit niet één enkele video maar uit een hele YouTube-afspeellijst of zelfs uit een kanaal. Download YouTube Facebook Vimeo en meer dan 50 andere websites extraheer audio van YouTube converteer online videos naar AVI MKV MP3 iPhone iPod. Kies de titel beschrijving en instellingen voor je video.
Sla ze op in SRT-formaat kies uit meer dan 50 talen. Met de gratis video-editor van Movavi ben je de regisseur van je eigen verhaal. We announced in 2019 that we would be migrating all classic Hangouts users to the new Meet and Chat products.
Download annotaties en ondertitels samen met YouTube-videos. Lil Nas X - MONTERO Call Me By Your Name Official Video Info. BSPlayer - the best multimedia player WebM HD and AVC video movie audio DVD YouTube in the world.
Now anyone with a Google Account can create an online meeting with up to 100 participants and meet for up to 60 minutes per meeting. Tik onderaan het scherm op Maken en selecteer Een video uploaden. VP9 video encoding support The VP9 codec offers a much higher image quality than the AVC aka Advanced Video Coding.
Google is making enterprise-grade video conferencing available to everyone. In order to provide enterprise-grade online video conferencing to everyone we announced a free version of Google Meet in May 2020. Real-time meetings by Google.
Nieuws en videos over loterij. De Europese Commissie wil vijf miljoen euro uittrekken om KLM-personeel dat vanwege de coronacrisis is ontslagen aan een nieuwe baan te helpen.
Geenstijl Corona Groningen Has Fallen
Drie mensen vertellen over hun coronabaan.

Baan verliest corona crisis wint 48 miljoen loterij video. Echtpaar geeft helft van 126 miljoen euro weg na winnen loterij. De versterkte maatregelen werden vastgelegd in een Ministerieel Besluit. Kersverse vader die baan verliest door coronacrisis wint 48 miljoen dollar in loterij Een kersverse vader uit Adelaide Australie die onlangs zijn baan verloor vanwege de coronacrisis hoeft nu helemaal niet meer te werken Hij bleek namelijk de winnaar te zijn van 48 miljoen Australische dollar omgerekend zon 28 miljoen euro te zijn.
Tegelijkertijd komt er werk bij dat eerder niet bestond. De crisis levert ook werk op deze mensen hebben juist door corona een baan. Het Rode Kruis is afhankelijk van donaties voor hun hulpverlening.
Door de pandemie met het coronavirus zullen in het tweede kwartaal wereldwijd 195 miljoen banen verloren gaan. Crisis bij McLaren. Betrouwbaar gratis en snel op NUnl de grootste nieuwssite van Nederland.
Ruim helft volwassenen in EU heeft minstens één prik gehad Meer dan de helft van de volwassenen in de EU-lidstaten heeft op dit moment minstens één dosis van een coronavaccin toegediend gekregen. Het schat in dat hiervoor 48 miljoen euro nodig is. Nog eens 140000 werknemers verloren hun baan.
In de eerste drie maanden van de coronacrisis werden officieel zon 60000 mensen werkloos. Vooral zorgen om werkgelegenheid flexwerkers na coronacrisis Meer dan in andere regios komt rond Amsterdam veel werkgelegenheid van sectoren die hard zijn geraakt door de coronacrisis. Er werden verschillende maatregelen genomen om de verspreiding van het virus te beperken.
Het heeft me gered van een persoonlijk faillissement. Het geld is bestemd voor de 1200 ontslagen. De Nationale Bank beklemtoont dat die cijfers alleen betrekking hebben op de werknemers.
Automobielconstructeur McLaren zal wegens de coronacrisis een einde maken aan de samenwerking met 1. Door corona dreigen er banen te verdwijnen. De ontwikkelingsorganisatie van de Verenigde Naties UNDP waarschuwde eerder dat de helft van de banen in Afrika verloren kan gaan door de crisis.
Marieke van Schaik directeur van het Rode Kruis stelt dat de organisatie middenin de tweede coronagolf mensen hun baan ziet verliezen en soms zelfs geen dak boven het hoofd hebben. De virusuitbraak zorgt vooral. Kwart miljoen Belgen dreigen baan te verliezen door corona.
Een echtpaar uit Noord-Ierland dat twee jaar geleden het astronomische bedrag van 115 miljoen pond omgerekend 126 miljoen. Coronacrisis leidt tot ongekende daling aantal banen. Maar het echte aantal ligt veel hoger.
In het tweede kwartaal van 2020 waren er 322 duizend banen minder dan een kwartaal eerder een afname van 30 procent. Het Rode Kruis schaalt de noodhulpverlening in Nederland substantieel op omdat de vraag om hulp tijdens de tweede coronagolf toeneemt. Dit cijfer geeft nog een geflatteerd beeld van de ontwikkeling van de werkgelegenheid omdat als gevolg van de coronacrisis in een deel van de banen niet of minder gewerkt.
Op donderdag 12 maart kondigde de Nationale Veiligheidsraad de federale fase van het crisisbeheer af. 1200 personen verliezen hun baan waarvan 70 betrokken bij de Formule 1.
Weer zon mooie opdracht afgerond. Harun B DUTCH videos-dutch Nass Van De Straten prod.
March 2 2016.

Van de straten prod harun b. De clip is één van de eerste Nederlandse muziekclips die te zien is in 4k HD 2160p. Nass - Van De Straten prod. Ismo - Zeg Die Mannen prod.
Ik vraag ook niks aan jou En de straten zijn heet. Chahid Nass ft Fissa - DÉCHAINER ClipOfficielBy RMidas P. Vanaf nu is hij in het wild te bewonderen in de straten van Gorinchem.
Omarbeats Nass - EMPIRE CLIP OFFICIEL NASS - Yessir. Boss Click - Bijlmer Style 2. Alsikgaverdienen is de 2e single van de aankomende EP van riffi genaamd ANDERSVoor Boekingen of andere vragen kun je mailen naar Ismomusichotmailnl Spot.
Harun B 16 October. Lyrics for this song have yet to be released. Harun B Ismo x Madina x Nass - Te Laat prod.
HBL - Dit Is Voor De B 6. Harun B 16 October 1 minute read by Youno. Harun B Nicki Minaj - MEGATRON Twerk with Nass Miami.
Chahid Nass - Voor Altijd prod. Boulevard in een AMG op jacht en ik ga in zee. Look what i found.
Harun B digitalmusicpaper. Nass Talent vd Maand Mei 101Barz. Nass Van De Straten Prod.
Ik ben flyyyy gelukkig zonder vliegangst Kijk wie dacht er aan mij Toen ik stond in de kou Beter vraag niks aan mij Ik vraag ook niks aan jou En de straten zijn heet En dat maakt mij soms lauw Ik geef geen fock om de blauw Ik geef geen fock om de blauw Fietsendief maar je speelt een wegpiraat Maar fucken met me money en weg piraat Ik krijg. Kiddo Cee - Kruimeldief 7. BEKIJK HIER DE VIDEO.
Nass Van De Straten prod. Ox Ismo - Ik Vraag Me Af ft. Darkside - Eer Van Mn Hood 8.
Get back voor mn niffos hoe ik die strap trek. KiMotion mocht hiervoor concept en ontwerp bedenken en uitvoeren. December 28 2020.
Nass Van De Straten prod. Unleaded Mb 4 September 1 minute read by Youno. Waar Ik Vandaan Kom Lyrics.
Nass WAWA prod. Een plek waar huurders en woningbouwvereniging elkaar ontmoeten en dichter tot elkaar kunnen komen. De Straten van Zuid-Oost by Bijlmer Style released 01 January 2007 1.
We eten van de straten neef ey yeah-yeah. ह गय ह लइपम. जन लइपम चरब क.
Submit a comment Cancel reply. Harun B REACTION DUTCH HIP-HOP. Nass - 3asses prod.
Fynne - Witwas Praktijken 5. Ik ga te fast mn banden scheuren op het wegdek gass. Nass - Van De Straten prod.
Ey H-H-Harun B Waar ik vandaan kom is het koud je moet de straten op Heb het gezien ervan gegeten en ook uitgekotst Kleine jongen hier met pijn loopt met een. Chahid Nass - Van De Straten prod. Vaderloze Troepe - Meer Vuur.
Nass - 22 Doezoe prod. AJ Watts - King Off The Ring 4. Previous Elliven Onderweg.
ads
Gaat Viral
Search This Blog
Blog Archive
- January 2023 (4)
- September 2022 (23)
- August 2022 (38)
- July 2022 (28)
- June 2022 (34)
- May 2022 (27)
- April 2022 (31)
- March 2022 (28)
- February 2022 (32)
- January 2022 (33)
- December 2021 (35)
- November 2021 (38)
- October 2021 (35)
- September 2021 (56)
- August 2021 (33)
- July 2021 (45)
- June 2021 (53)
- May 2021 (29)
- April 2021 (40)
- March 2021 (34)
- February 2021 (56)
- January 2021 (39)
- December 2020 (39)
- November 2020 (39)
- October 2020 (43)
- September 2020 (40)
- August 2020 (36)
- July 2020 (35)
- June 2020 (48)
- May 2020 (43)
- April 2020 (44)
- March 2020 (45)
- February 2020 (32)
- January 2020 (41)
- December 2019 (41)
- November 2019 (41)
- October 2019 (59)
- September 2019 (38)
- August 2019 (51)
- July 2019 (42)
- June 2019 (38)
- May 2019 (17)
Labels
- 0fux
- 101barz
- 1200
- 1429
- 1994
- 1oak
- 2020
- 2021
- 2050
- 21savage
- 24ojo
- 3robi
- 50ms
- 6ix9ine
- aalsmeer
- aangeklaagd
- aangereden
- aangevallen
- aanleiding
- aanspreekt
- aantrekkelijkst
- aantrof
- aanval
- aarde
- aart
- abdu
- abel
- aboutaleb
- account
- achter
- achternaam
- achtervolgd
- achtervolgt
- achtige
- activist
- actrice
- adje
- advies
- advocaat
- afgelopen
- afgevallen
- afgevoerd
- afgewezen
- afgrond
- afkomst
- aflevering
- afspreken
- agent
- agenten
- agressieve
- ahammoud
- airpods
- ajax
- alaka
- alaska
- albert
- album
- alcohol
- alex
- alexander
- alexia
- alias
- aliyah
- allang
- alle
- alleen
- allemaal
- alles
- alone
- alsjeblieft
- alsof
- alweer
- amanda
- amerikaanse
- amiri
- amsterdam
- anbu
- andere
- andre
- angst
- angstaanjagende
- aparte
- apeldoorn
- apollo
- apple
- april
- architrackz
- arrest
- artiest
- ashafar
- asiah
- australia
- auto
- autodealer
- autos
- avatar
- avenue
- avondklok
- award
- ayoub
- azarkan
- baan
- baba
- baby
- bachelorette
- badkamer
- badr
- balance
- balk
- ballieman
- ballonnen
- ballonnenverslaving
- balonnen
- bandoo
- bang
- bankrolls
- barcelona
- baron
- barricade
- barrio
- bars
- barst
- barz4dayz
- basic
- baudet
- beach
- beatbox
- beats
- beatz
- bedreigd
- bedreigen
- bedreigingen
- bedreigt
- beek
- beeld
- beelden
- beest
- begint
- begrijpen
- beheerst
- behoorde
- bekend
- bekende
- bekendgemaakt
- bekogeld
- bekogelen
- belaagd
- belachelijk
- belachelijke
- belangrijke
- bell
- bella
- beloning
- bemoeien
- benen
- benmbarek
- benn
- bent
- bentleys
- bericht
- berichten
- beroof
- beroofd
- berooft
- beroven
- beschermen
- beschoten
- beschuldig
- beschuldigd
- beschuldigingen
- beslag
- besluit
- besmetting
- besmettingen
- besparen
- bespuugd
- bespuugt
- best
- beste
- bestelling
- bestolen
- bestorming
- bestrijdt
- betaalt
- betalen
- betekenis
- betrapt
- bevallen
- beveiliger
- beveiligster
- bewaker
- bewijs
- bezoek
- bezoeker
- bezorgd
- bezorger
- bhabie
- biden
- bieber
- bied
- biedt
- bier
- bigger
- biggie
- bijna
- bijzonder
- bijzondere
- bilal
- billen
- bilvergroting
- binnen
- biografie
- birthday
- bitcoin
- bizar
- bizzey
- blaaser
- blaast
- black
- blacka
- blanke
- blauwe
- blaxx
- blijkt
- bliksem
- blind
- bloederige
- bloot
- blote
- blowen
- blunder
- body
- boef
- boek
- boete
- boetes
- boevenklok
- boevenpak
- bokke8
- bomexplosie
- bonneke
- boodschap
- boos
- bosch
- boxing
- boyd
- bram
- brand
- bravo
- break
- breez
- breghje
- breken
- breng
- brengt
- brent
- breuk
- brief
- britney
- broedermoordaanslag
- broer
- broers
- broertje
- bron
- bronnen
- broodje
- brooks
- brothers
- bruijn
- brute
- bryant
- btch
- budha
- buikje
- buiten
- buren
- burenruzie
- burgemeester
- burgermeester
- busje
- buurman
- buurt
- buzzfeed
- cadeau
- callcenters
- calma
- camera
- cancellen
- capaciteit
- capslocked
- cardi
- carierre
- carmel
- carnaval
- carpenter
- cash
- catch
- catfish
- caza
- cent
- chahid
- challenge
- challenges
- champagne
- chaos
- chapo
- chasers
- chatgesprekken
- cheetah
- chimi
- chinese
- chips
- chiviv
- chivv
- chuchu
- chuki
- cimpel
- cinar
- clip
- coca
- cola
- collectie
- commandeert
- compleet
- complete
- confrontatie
- confronteert
- confronteren
- conor
- controlepost
- controversiele
- corinthians
- corona
- coronaboetes
- coronadebat
- coronamaatregelen
- coronaregels
- coronavirus
- cover
- covid
- crasht
- creert
- crisis
- crypto
- crzy
- curacao
- cypher
- daarna
- dababy
- dacht
- daddies
- daddy
- dader
- dagen
- dakloze
- dame
- danny
- dansen
- dario
- dariosantana
- date
- daten
- datum
- dave
- davey
- david
- dchar
- dealers
- debat
- deden
- deed
- deeg
- deel
- deelden
- deelneemster
- deelnemer
- deelnemers
- deelt
- defenitie
- deja
- delany
- demonstratie
- deniz
- denken
- denkt
- deno
- denta
- depay
- derksen
- desi
- details
- detentie
- deur
- deze
- diamand
- diamonds
- dicht
- dieven
- dikke
- dikstedrerrie
- diplo
- diquenza
- dirty
- discussie
- disney
- diss
- dist
- distance
- djaga
- djermo
- djezja
- dochter
- doen
- does
- doet
- doja
- dollar
- domeinnaamzwendel
- donalds
- donerverkoper
- donkere
- donnie
- donovan
- dont
- dood
- doodsbedreigingen
- doodsoorzaak
- door
- doorgaan
- doorheen
- dopeboy
- dopebwoy
- dopingmiddel
- dorentina
- douchen
- down
- downloaden
- draait
- dragen
- dragon
- drankspel
- drill
- drillrapper
- drinken
- drinkt
- droom
- droppen
- dropt
- drugs
- drugsdealer
- drugsverkoop
- drukte
- dubai
- dubbel
- duiken
- duikt
- duman
- dutty
- duurt
- dwdd
- dylvn
- e11even
- echt
- echte
- echtpaar
- eddyani
- eduson
- eenhoornjoost
- eerlijk
- eerst
- eerste
- eeuw
- effe
- effs
- eigen
- eilish
- einde
- eindstand
- elkaar
- ellen
- ellens
- emile
- eminem
- emms
- emmy
- emotioneel
- endz
- enige
- enschede
- erachter
- erica
- ertu
- escaleert
- esko
- euro
- excuses
- explosie
- exposed
- expres
- extreem
- eyes
- ezhel
- fabiola
- facce
- familie
- family
- famke
- fane
- fans
- faraostad
- favela
- fcked
- feat
- feest
- feit
- felix
- fellas
- fenomeen
- festivalseizoen
- feyenoord
- fielz
- fifa
- figogang
- fillers
- filmpje
- films
- finesse
- flauw
- flex
- flippen
- flipt
- floyd
- flying
- fooi
- formule1
- forum
- foto
- fotos
- fotoshop
- fous
- fout
- fraasie
- frankrijk
- frans
- fraser
- fraudeurs
- freestyle
- french
- frenna
- friends
- frnkie
- froduction
- froger
- from
- functie
- funhouse
- gaan
- gaat
- gabriels
- gaby
- game
- games
- gang
- gannoe
- gast
- gasten
- gaza
- geaccepteerd
- gearresteerd
- gebruik
- gebruiken
- gebruikers
- gebruikt
- geconfronteerd
- gediskwalificeerd
- gedist
- geechi
- geeft
- geen
- geert
- gegeven
- gehad
- gehandicapte
- geheim
- geheime
- gekloond
- gekocht
- gekregen
- gelato
- geld
- geldvraag
- geleden
- gelekt
- gelekte
- gelokt
- gelost
- gelukt
- gemaakt
- genaamd
- genomen
- george
- geruchten
- geschiedenis
- geschokt
- gesigneerde
- geslachtsdeel
- geslagen
- geslepen
- gesnitched
- gespaard
- gespot
- gestolen
- gestopt
- gestuurd
- getekend
- geuze
- gevaarlijk
- gevaarlijker
- gevaccineerd
- gevangenen
- gevangenis
- gevangenisfoto
- gevangenissen
- gevangenisstraf
- gevecht
- geven
- gevloerd
- gevonden
- geweest
- gewelddadige
- gewonde
- gewoonbeats
- geworden
- gezicht
- gezien
- gezin
- gezond
- gezondheidsproblemen
- ghetto
- ghosen
- gideonite
- gigantische
- gijzelen
- gilles
- ging
- ginton
- girl
- girls
- glen
- glitch
- gloednieuwe
- godverdmme
- goed
- gokmen
- good
- gotu
- goud
- grace
- grande
- grappen
- gratis
- grazen
- greet
- gregg
- grgy
- groep
- groepje
- groningen
- groot
- grootste
- grote
- gruwelijke
- guala
- haag
- haalt
- haar
- hack
- hacker
- hackt
- hackten
- hadid
- hakmes
- halen
- halfnaakte
- hallo
- hamer
- hamsteren
- hand
- handelen
- handen
- handtastelijke
- hard
- hardhandig
- hari
- harun
- harvey
- hater
- haters
- hawk
- hayat
- hazes
- head
- heavy
- hebben
- hebt
- heeft
- heeftvideo
- heel
- heen
- hefner
- heftig
- heftige
- heijn
- hele
- helemaal
- helikopterongeluk
- helpt
- henkie
- herres
- hersenchip
- hier
- hierdoor
- hierover
- hilarisch
- hirak
- hofman
- hoge
- hoger
- holleeder
- hollywoodster
- holwijn
- home
- homo
- homos
- hond
- honden
- hood
- hoody
- hooligan
- hoop
- hoort
- horen
- horloge
- horloges
- hotel
- hotels
- hotwings
- houden
- houdt
- hugo
- huilend
- huilende
- huis
- huisarts
- huit
- hulp
- humble
- hyena
- hype
- icey
- iconic
- idols
- iedereen
- iets
- illegaal
- ilyas
- inbreker
- incfluencer
- incident
- indruk
- influencer
- influencers
- informativ
- ingebroken
- ingesloten
- ingesproken
- inside
- insta
- intensive
- internationaal
- internet
- interview
- interviewt
- intro
- inval
- ipema
- iphone
- ipupa
- iraans
- islam
- island
- ismail
- ismo
- israel
- israelische
- italie
- izzy
- jaar
- jack
- jackmillion
- jager
- jalal
- james
- jarig
- jarige
- jasonxm
- jaybeatz
- jazz
- jeans
- jebroer
- jeffrey
- jenner
- jeruzalem
- jesse
- jessie
- jesus
- jeugdgevangenis
- jeugdwedstrijd
- jlbeatz
- joanne
- joey
- johannes
- john
- johnny
- joke
- jong
- jongen
- jongens
- jongeren
- jongetje
- jonna
- jordaan
- jordy
- josylvio
- juice
- juiste
- junior
- jury
- juwelier
- kaag
- kaal
- kabinet
- kaff
- kaki
- kallah
- kalvijn
- kamer
- kampioen
- kanaal
- kantine
- kanye
- kapot
- kapsel
- kardashian
- kareem
- karma
- kast
- kastiop
- keer
- keerzijde
- keihard
- kerkganger
- kerstcadeautjes
- kersttfilm
- kersverse
- kettingrukker
- keuze
- kevin
- keyser
- khabib
- khaled
- khalifa
- khoya
- kiemeney
- kifes
- kijk
- kijken
- kijkers
- kill
- kilos
- kind
- kinderen
- kinderprno
- king
- kist
- klaagt
- klagen
- klant
- klein
- kleine
- kleinzoon
- kleuter
- klif
- klimt
- kluivert
- knap
- knkerhomos
- knock
- knol
- knopen
- knuffelend
- kobe
- kodak
- komen
- komt
- koning
- koningsdag
- kookshow
- koop
- koopt
- kopen
- koran
- koreaanse
- kosso
- kost
- koussour
- kraantje
- krabman
- krijg
- krijgen
- krijgt
- kritiek
- kritische
- kroongetuige
- kross
- kuipers
- kunnen
- kurt
- kwaad
- kwijt
- kyan
- laat
- label
- lach
- lady
- lakeisha
- lakens
- lamborghini
- lamborghinis
- lanez
- lang
- lange
- langere
- langford
- langs
- langste
- langzaam
- lastig
- lastige
- late
- laten
- latooy
- lauren
- laurent
- laverne
- leeftijd
- leetijd
- legende
- legends
- leger
- legt
- leidt
- lekker
- leraar
- lerares
- lesje
- lesley
- lessons
- leven
- levende
- levy
- lexxxus
- lezen
- lichaam
- licht
- lief
- liefde
- liefdesgeruchten
- liefdesverdriet
- liever
- lightwork
- lijkt
- lijn
- lijntje
- lijpe
- lijstje
- likte
- lingo
- lipstick
- liselotte
- list
- live
- lives
- livestream
- lobi
- lockdown
- logan
- loods
- looft
- look
- loopt
- lopen
- lopes
- lorente
- louise
- louivos
- love
- loyal
- lubach
- lucasdante
- lucass
- lucky
- maagdelijkheid
- maak
- maakt
- maan
- maar
- maatman
- maatregelen
- machine
- macron
- maffia
- magicknocker
- magisch
- major
- make
- maken
- makenvideo
- malik
- maling
- malkova
- mama
- manager
- manier
- mannen
- maps
- maradona
- maradonna
- mark
- marokkanen
- marokko
- marone
- martien
- maserati
- maseratii
- masker
- massaal
- matarazzo
- matter
- mauro
- mayweather
- mcgregor
- mdma
- medewerker
- medewerkers
- media
- medisch
- meelopen
- meer
- meesdix
- meest
- meeste
- meet
- meiland
- meisje
- meisjes
- meldt
- memphis
- mendes
- mening
- mensa
- mensen
- menu
- messengeweld
- meteen
- metroboomin
- mezelf
- middel
- mijn
- miljoen
- milzink
- minderjarig
- minderjarige
- mini
- minister
- miro
- misbruikbeschuldiging
- misgaan
- misgelopen
- mishandeld
- mittaa
- mmpm
- mobicep
- mocro
- mocromaffia
- mocromaniac
- mode
- model
- moeder
- moedermelk
- moeman
- moest
- moet
- moeten
- mogelijk
- mogelijke
- mogen
- momenten
- mondkapje
- mondkapjes
- mondkapjesplicht
- money
- monsifs
- monster
- montana
- mooiste
- moord
- moordenaar
- moormeier
- moskee
- motion
- motoragent
- mucky
- muil
- mula
- museumplein
- music
- musk
- mute
- muteren
- muziek
- mysterieus
- naakt
- naaktfotos
- naam
- naar
- nadat
- nagellak
- najih
- nassim
- navi
- nederland
- nederlander
- nederlandse
- neemt
- neergeschoten
- neergestoken
- neergezet
- neerzetten
- negativiteit
- nelson
- nemen
- nephorloge
- neppe
- never
- nielson
- niet
- nieuw
- nieuwe
- nieuws
- niffer
- night
- nikkietutorials
- niks
- nnelg
- noahs
- nodig
- nodigt
- noemen
- noemt
- nooit
- noriega
- normaal
- notch
- note
- nouri
- nummer
- oath
- oetan
- official
- officiele
- ogen
- omari
- omdat
- omroep
- onbeperkte
- onder
- onderbroek
- onderbroeken
- onderbroken
- ondergaat
- ondergedoken
- onderneemt
- onderweg
- onderzoekt
- ongeluk
- ongemakkelijke
- only
- onlyfans
- onrecht
- onstaat
- ontcijferd
- ontdekken
- ontdekking
- ontdekt
- onthult
- ontkent
- ontmoet
- ontmoeting
- ontslag
- ontslagen
- ontsnappen
- ontsplag
- ontstaan
- ontvangt
- ooit
- oomto
- oorlog
- oost
- open
- operatie
- opgedoken
- opgelicht
- opgenomen
- opgepakt
- opgezette
- opgroeien
- ophef
- oplichter
- oplichters
- opmerkelijk
- opnieuw
- opstootje
- optreden
- ouaali
- oude
- oudere
- ouders
- oussama
- outfit
- over
- overeem
- overijssel
- overleden
- overledene
- overtreedt
- overval
- overvallen
- overwinningsspeech
- paard
- pakken
- pakul
- palenko
- palestina
- paniek
- paniekaanval
- panky
- papier
- pappie
- parker
- part
- partij
- patient
- patron
- paul
- peace
- pedfielen
- pedofielen
- pedofilie
- pepe
- pepperspray
- persoon
- phill
- pierards
- pierrii
- piet
- pijnlijk
- pijp
- pikt
- pistool
- plaatje
- plaatsen
- plaatst
- plat
- playstation
- plekken
- plessen
- plofkraak
- plots
- plunderen
- pluto
- poarch
- poep
- poke
- politie
- politiebureau
- polo
- polska
- pommelien
- pons
- poppen
- porsche
- post
- postpakketjes
- potjes
- power
- powned
- ppcocaine
- praat
- prachtig
- prachtige
- precies
- presentator
- presenteert
- presents
- president
- prijzen
- prikken
- prime
- prinses
- probeerde
- probeert
- proberen
- problem
- problemchild
- prod
- producedbyezra
- producer
- proeven
- profvoetballer
- programma
- project
- publiceert
- publiciteitsgel
- publieke
- puin
- pushed
- qifesh
- qlas
- quarantaine
- qucee
- quesada
- questions
- quinna
- quiz
- racistische
- raden
- radiozender
- ramkraak
- randen
- range
- rango
- rapgroep
- rappende
- rapper
- rappers
- rapster
- rapt
- rapvideos
- ratten
- rauw
- rave
- rayvanny
- razzouki
- rdvdtf
- reactie
- reacties
- reageerde
- reageert
- reageren
- rechter
- rechters
- reden
- redt
- redwingz
- regels
- reid
- reken
- relatie
- release
- rellen
- remedies
- remix
- rene
- renkema
- rest
- restaurant
- reverse
- rhoades
- rico
- rihanna
- rijden
- rijdt
- risico
- risicos
- riskeert
- ritchye
- rivelino
- robinson
- rocco
- rockywhereyoubeen
- rocwell
- rode
- rodenburg
- rodrigo
- rody
- roelvink
- roept
- roets
- rokje
- rolex
- roll
- rolls
- rolstoelboxen
- romana
- ronaldinho
- ronaldo
- ronaldos
- rondleiding
- ronnie
- rood
- rookbom
- rosa
- rotterdam
- rotterdamse
- rover
- rovers
- royce
- rozenstruik
- rumba
- rustig
- rutte
- ruttes
- ruzie
- saaff
- said
- saint
- salar
- salaris
- salisounzz
- sambo
- samen
- samenwerking
- samski
- sarah
- saudi
- savage
- saweetie
- sbmg
- scammers
- scarface
- schaam
- schaamtegevoel
- schade
- scheiden
- scheiding
- schiet
- schieten
- schietpartij
- schijt
- schilderswijk
- schmeltz
- schokkende
- schouten
- schreeuwen
- schreeuwt
- schrijft
- schrikt
- schudt
- scooterrijder
- scootmobiel
- scott
- script
- seizoen
- sellah
- serie
- serop
- sessie
- sevn
- sexyfotos
- shabir
- shafique
- shock
- shockeert
- shockeren
- shockerende
- shoot
- show
- shower
- sides
- simons
- sinds
- singa
- sirene
- situatie
- slaan
- slaapt
- slaat
- slachtoffer
- slapen
- slecht
- slijptol
- slikken
- sloeg
- slopen
- sluiten
- smaakmakers
- smeren
- smit
- smitmeister
- smoesjes
- smoke
- snap
- snapchat
- sneeuwballen
- sneeuwscheppen
- snijders
- snuiven
- soelen
- sokken
- somebody
- soms
- songfestival
- soort
- souley
- soundflow
- soze
- sozes
- spaargeld
- spanker
- spears
- speech
- spel
- spelen
- spiderman
- spiegel
- spijt
- spiritual
- spoort
- sportschool
- spot
- spotten
- spreekt
- spreken
- spullen
- srno
- staande
- staat
- staatsloten
- stack
- stal
- stampen
- staredown
- start
- statistieken
- steekt
- steelt
- stegeman
- steken
- stelen
- stem
- ster
- sticks
- stiekem
- stoep
- stoer
- stond
- stop
- stoppen
- stoute
- straat
- straatroof
- straf
- straft
- stream
- streamen
- studeert
- student
- studenten
- studio
- stuk
- stuktv
- stunt
- stuur
- styn
- succes
- super
- switch
- talent
- talk
- tanden
- tattoo
- taylorr
- teekay
- teemong
- tegen
- tegenstander
- telefoon
- televisie
- temptaion
- temptation
- tentamens
- terroriseert
- terroristische
- terug
- terugkrijgen
- teruglezen
- terwijl
- test
- than
- thats
- thee
- thez
- thierry
- thorne
- tiener
- tieners
- tiffany
- tiffin
- tijdens
- tikkie
- tiktok
- tiktokkers
- tiktokster
- time
- timing
- timo
- tisdale
- toch
- toekomst
- toen
- toestemming
- tonic
- toont
- topparty
- total
- track
- trailer
- train
- tranen
- transformatie
- transgender
- trap
- treft
- trein
- trekt
- trend
- trevejo
- trill
- trivia
- truc
- trump
- tuin
- tupac
- tussen
- tweede
- tweet
- twerk
- twerkende
- twins
- tyson
- ubereats
- uiteindelijk
- uitgekotst
- uitgelekt
- uitgelicht
- uitgemelkt
- uitkomt
- uitleg
- uitlekken
- uitschold
- uitspraak
- uitsprak
- uitspraken
- uitziet
- un4gettable
- unleaded
- utrecht
- vaccin
- vaccineren
- vader
- vaes
- vakantie
- valentijns
- vallen
- valsspelen
- valt
- vanaf
- vandam
- vanherle
- vanno
- vanuit
- vanwege
- vast
- vaste
- vastgelegd
- vastzat
- vecht
- vechten
- vele
- verandering
- verbaast
- verbinding
- verbreekt
- verdacht
- verdedigen
- verdejo
- verdiend
- verdiende
- verdienden
- verdienen
- verdient
- verdieping
- vergeet
- verhaal
- verhoeven
- verjaardag
- verkeerde
- verklaring
- verkoop
- verkoopt
- verkrachten
- verleidster
- verlies
- verliest
- verliezer
- verloofde
- verloren
- vermist
- vermogen
- vermoord
- vernielen
- veronica
- veroordeeld
- verplicht
- verrast
- versieren
- verslaggever
- verslaggevers
- verstopte
- vert
- vertellen
- vertelt
- vertrouwen
- vervelend
- verwelkomt
- verwijderd
- verwijdert
- verwoest
- video
- videoclip
- videos
- viespeuk
- viezerik
- villa
- vind
- vindt
- vintage
- violet
- viraal
- viruswaarheid
- vision
- vixen
- vlaardingen
- vlado
- vlag
- vlees
- vlieg
- vliegende
- vliegt
- vliegtuig
- vlucht
- vluchteling
- voelt
- voetbalsupporters
- voice
- volgende
- volgers
- volgt
- volledige
- vondelpark
- vonneke
- voor
- voorspelt
- vraagt
- vragen
- vreemdgaan
- vreemdgaat
- vriend
- vriendin
- vriendinnen
- vriendje
- vrij
- vroeger
- vrouw
- vrouwelijke
- vrouwen
- vuilnisman
- vuur
- vuurwerk
- waard
- waarheid
- waarin
- waarom
- waarschuwt
- wageningen
- wahib
- wakka
- wakker
- walgelijk
- walker
- wallin
- wally
- wanna
- wapen
- wapenbezit
- wapenvideo
- warning
- washington
- water
- wave
- waves
- wawa
- waylon
- wayne
- wedstrijd
- weer
- weggestuurd
- wegloopt
- weigeren
- weigert
- wennen
- wereld
- wereldrecord
- werk
- werken
- werknemer
- wesley
- west
- whale
- while
- whiteboy
- whole
- whos
- wijnaldum
- wijze
- wiki
- wilde
- wilders
- willem
- willen
- willybeatsz
- winkel
- winkels
- winkelwagentje
- winkler
- winnaar
- winnen
- wint
- winter
- wintersessie
- wist
- witzenhausen
- woedend
- wolfhard
- woonplaats
- woonwijk
- word
- worden
- wordt
- work
- wraak
- wraakprno
- wright
- wrld
- yade
- yasmine
- yassine
- yassinebeats
- yasz
- yayo
- yolanthe
- york
- youness
- young
- youtube
- youtuber
- yssi
- yung
- zach
- zack
- zandloper
- zanger
- zangeres
- zegen
- zegt
- zeker
- zeldzame
- zelf
- zendt
- zerodix
- zeta
- zetten
- zich
- zichzelf
- ziegler
- ziek
- ziekenhuis
- ziekenhuizen
- zien
- ziet
- ziggy
- zijn
- zingt
- zinkende
- ziyech
- zoek
- zoeken
- zoenen
- zoent
- zomaar
- zomersessie
- zonder
- zoom
- zoon
- zoontje
- zorgde
- zorgen
- zuiden
- zuiderhoek
- zusje
- zwaar
- zwaargewond
- zwanger
- zwangere
- zwarte
- zwarts
- zwembad
- zwijndrecht
